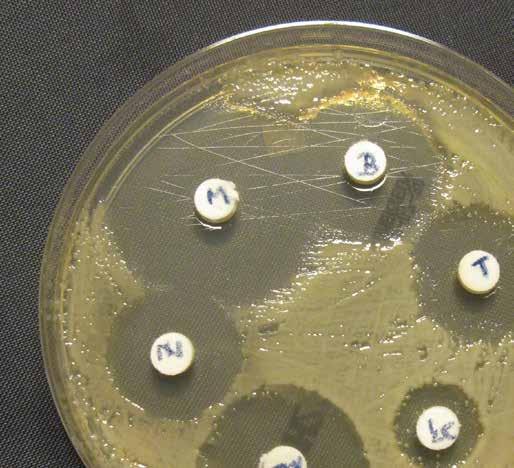

„Zurück zur Natur bringt uns der Gesundheit einen Schritt näher“



„Zurück zur Natur bringt uns der Gesundheit einen Schritt näher“
So viele zufriedene Seminarteilnehmer:innen und großartige InhouseSeminare unserer Referent:innen in Krankenhäusern und Pflegeeinrichtungen! Es ist immer wieder schön zu sehen, wie Wissen Menschen zusammenbringt und dazu beiträgt, mehr Wohlbefinden und Gesundheit in unser Berufsleben und unseren Alltag zu integrieren. Daher bin ich besonders stolz, dass wir unseren langjährigen Herzenswunsch verwirklichen konnten: Unser eigenes Aromapflegezentrum mit Schule und Flagship Store!
Unser Aromapflegezentrum öffnete Anfang Juni in der Margaretenstraße 52 im 4. Bezirk in Wien. Es vereint die renommierte Gesundheitsschule Evelyn Deutsch mit einem 100 m² großen Ladengeschäft und ist ein zentraler Anlaufpunkt für alle Gesundheitsbewussten. Hier kannst Du Beratungen zur Aromapflege in Anspruch nehmen, Produkte ausprobieren, bei Bio-Tee oder Bio-Kaffee entspannen, Netzwerke knüpfen oder in der Leseecke in Büchern stöbern.
In unserer Gesundheitsschule bieten wir nun regelmäßig Kurzvorträge in Präsenz und online an. Ideal für alle, die sich schnell und fundiert über spezielle oder aktuelle Themen informieren möchten. Diese bieten einen ersten Einblick in unsere umfassenderen Seminare.
Ich freue mich besonders, Prof. DDDr. Hans Hatt wieder als unseren Referenten mit seinem Seminar „Niemand riecht so gut wie Du“ begrüßen zu dürfen. Zudem darf ich zwei weitere neue Seminare ankündigen: „Aromapflege in der Geriatrie“, ein Fachseminar mit EvaMaria Rudorfer, BScN, und „Cool bleiben in den Wechseljahren“ mit Carmen Riegler. Auf vielfachen Wunsch und weil uns der ökologische Fußabdruck am Herzen liegt, haben wir entschieden, unseren Aromapflege-Fans im Süden Österreichs entgegenzukommen und künftig Seminare in Graz anzubieten.
Ich lade Dich nun herzlich ein, unsere Gesundheitsschule Evelyn Deutsch zu besuchen, wo Kurzvorträge, Workshops, Seminare und eine große Auswahl an Naturprodukten auf Dich warten.
Deine
Evelyn Deutsch-Grasl, AE
Pflegepersonen* erhalten Fortbildungsstunden (= Maßnahmenstunden).
1 Fortbildungsstunde (FBS) = 1 Unterrichtseinheit (UE) à 45 Minuten. Die Anzahl der absolvierten Maßnahmenstunden wird im Symbol angezeigt.
Seminar kann auch als innerbetriebliche Fortbildung für Teams bis maximal 20 Personen gebucht werden. Referent:in kommt persönlich ins Haus.
Seminar ist live & interaktiv und findet zu einem festen Termin im Internet statt. Bei Buchung Web-Seminar inkl. Seminarpaket mit Seminarunterlagen und Arbeitsmaterial (per Post).



Teilnahme am Seminar setzt Aromapflege-Grundwissen über ätherische Öle, fette Pflanzenöle sowie deren Dosierung und Anwendung voraus.
Seminar ist neu und wird von uns zum ersten Mal angeboten.
* Pflegepersonen sind gemäß § 63 bzw. § 104c GuKG verpflichtet, innerhalb von fünf Jahren 40 Fortbildungsstunden für Assistenzberufe bzw. 60 Fortbildungsstunden für den gehobenen Dienst zu absolvieren.
Seminar findet sowohl als Präsenz-Veranstaltung in der Schule als auch online über eine Videokonferenz-Plattform statt. Bei Buchung Hybrid-Seminar inkl. Seminarpaket mit Seminarunterlagen (per Post).

praxisorientiert | lebendig | abwechslungsreich
• Maximale Flexibilität durch 100% Online-Lernen
• Kein zusätzlicher Aufwand für die Anreise
• Einfache Teilnahme ohne Installationsaufwand, da browserbasiert
• Lerninhalte in Umfang & Qualität gleichwertig mit Präsenz-Seminaren
• Umfangreiches Schulungsmaterial wird bereitgestellt
• Zahlreiche interaktive Elemente und praktische Übungen
• Laufende Überprüfung des aktuellen Wissensstands
• Freischaltezeitraum beträgt 6 Monate ab Buchungsdatum
• Fortbildungen gemäß § 63, § 104c GuKG
• Anrechenbare Fortbildungsstunden (= Maßnahmenstunden)
• Teilnahmebestätigung nach Abschluss
• Nach Abschluss wirst Du bei uns als VIP-Kunde eingestuft (siehe Seite 54)
• Wird dem Basis- und Aufbaulehrgang angerechnet

Unsere E-Learnings bieten Dir die Möglichkeit, ausgewählte Seminare von jedem Ort der Welt aus zu jeder Zeit und in Deinem eigenen Tempo zu absolvieren.
Wir haben die Lerninhalte unserer beliebten Präsenz-Seminare – Aromapflege Einführung, Aromapflege Fortsetzung und Aromapflege bei Demenz – in zahlreichen Filmen aufgearbeitet. Mit vielen Einblendungen, animierten Grafiken und Videos, die die Pflanzen zum Leben erwecken, gestalten wir die einzelnen Module abwechslungsreich und lebendig. Wir binden Dich aktiv ein, indem wir zahlreiche Quizfragen, Praxisaufgaben und Riechübungen integrieren. Deine persönliche Schulungsbox mit Riechund Produktproben ist dabei ein fester Bestandteil unseres E-Learning-Angebots.
Alle E-Learnings sind Fortbildungen laut § 63, § 104c GuKG mit anrechenbaren Maßnahmenstunden (= Fortbildungsstunden). Nach erfolgreichem Abschluss des E-Learnings erhältst Du eine Teilnahmebestätigung.
Mehr Details & Anmeldung: www.aromapflege.com/e-Learning

31.01.2025
10. + 11.02.2025
28.02.2025
05. + 06.03.2025
11.03.2025
13.03.2025
14.03.2025
31.03.2025
02. + 03.04.2025
07. + 08.04.2025
24.04.2025
28.04.2025
30.04.2025
07.05.2025
09.05.2025
13. + 14.05.2025
20. + 21.05.2025
02. + 03.06.2025
05.07.2025
09. + 10.09.2025
19.09.2025
23.09.2025
Riechtraining fürs Gehirn | Maria Christina Margreiter, BScN
Aromapflege Einführung | Evelyn Deutsch-Grasl, AE
Cool bleiben in den Wechseljahren | Carmen Riegler
Aromapflege Fortsetzung | Carmen Riegler
Aromapflege im Wundmanagement | Eva-Maria Rudorfer, BScN
Aromapflege bei Demenz | Carmen Riegler
Aromapflege in Ordination und Ambulanz | Carmen Riegler
Aromapflege in der Geriatrie | Eva-Maria Rudorfer, BScN
Aromapflege Einführung | Evelyn Deutsch-Grasl, AE
Biologische Hautpflege | Ruth von Braunschweig
Aromapflege und Recht | Mag. Dr. Christian Gepart
Aromapflege in der Palliative Care | Alicia Lanzerstorfer, BScN
Vital und gesund durch Alltag & Beruf | Carmen Riegler
Aromapflege bei Stress, Burnout & Depression | Cornelia Mögel
Schmerz lass nach | Esther Schauberger
Psychische Gesundheit fördern mit Aromapflege | Carmen Riegler
Aromapflege Fortsetzung | Carmen Riegler
Aromapflege Praxistage | Carmen Riegler
Niemand riecht so gut wie Du | Prof. DDDr. Hans Hatt
Aromapflege Einführung | Evelyn Deutsch-Grasl, AE
Vital und gesund durch Alltag & Beruf | Carmen Riegler
Aromapflege in der Geriatrie | Eva-Maria Rudorfer, BScN
25.09.2025 So gelingt Aromapflege | Doris Kamleitner, BScN MA
30.09. + 01.10.2025
Aromapflege Fortsetzung | Carmen Riegler
03.10.2025 Cool bleiben in den Wechseljahren | Carmen Riegler
04.10.2025
07.10.2025
17.10.2025
21.10.2025
23.10.2025
04.11.2025
12. + 13.11.2025
14.11.2025
17.11.2025
19. + 20.11.2025
03. + 04.12.2025
16. + 17.12.2025
Aromatogramm | Dr.in Gerda Dorfinger
Schmerz lass nach | Esther Schauberger
Aromapflege bei Stress, Burnout & Depression | Cornelia Mögel
Aromapflege im Wundmanagement | Eva-Maria Rudorfer, BScN
Aromapflege und die Wissenschaft | Doris Kamleitner, BScN MA
Aromapflege bei Demenz | Carmen Riegler
Psychische Gesundheit fördern mit Aromapflege | Carmen Riegler
Aromapflege in Ordination und Ambulanz | Carmen Riegler
Aromapflege in der Palliative Care | Alicia Lanzerstorfer, BScN
Aromapflege Einführung | Evelyn Deutsch-Grasl, AE
Aromapflege Fortsetzung | Carmen Riegler
Aromapflege Praxistage | Carmen Riegler
05. + 06.05.2025 Aromapflege Einführung | Evelyn Deutsch-Grasl, AE
16.05.2025 Vital und gesund durch Alltag & Beruf | Evelyn Deutsch-Grasl, AE
26.09.2025 Cool bleiben in den Wechseljahren | Carmen Riegler
16. + 17.10.2025 Aromapflege Fortsetzung | Evelyn Deutsch-Grasl, AE
06. + 07.11.2025 Aromapflege Praxistage | Evelyn Deutsch-Grasl, AE
27.+28.02 2025 Aromapflege Einführung | Eva-Maria Rudorfer, BScN
10.04.2025 Aromapflege im Wundmanagement | Eva-Maria Rudorfer, BScN
04.06.2025 Aromapflege in der Palliative Care | Eva-Maria Rudorfer, BScN
06.06.2025 Aromapflege bei Demenz | Eva-Maria Rudorfer, BScN
09.10.2025 Aromapflege im Wundmanagement | Eva-Maria Rudorfer, BScN
10.10.2025 Aromapflege bei Demenz | Eva-Maria Rudorfer, BScN
06.11.2025 Aromapflege in der Palliative Care | Eva-Maria Rudorfer, BScN
Web-Seminar
20.02.2025 Aromapflege in der Palliative Care | Alicia Lanzerstorfer, BScN
28.03.2025 Schmerz lass nach | Esther Schauberger
25. + 26.11.2025 Biologische Hautpflege | Ruth von Braunschweig
28.11.2025 Die pflanzliche Apotheke für Haustiere | Dr.in med. vet. Alexandra Nadig
29.11.2025 Viren, Bakterien & Parasiten bei Haustieren | Dr.in med. vet. Alexandra Nadig
Hybrid-Sminar
25.09.25 So gelingt Aromapflege | Doris Kamleitner, BScN MA
23.10.25 Aromapflege und die Wissenschaft | Doris Kamleitner, BScN MA
Die Aromapflege-Bildungspyramide ist speziell für Pflegepersonen aus dem Gesundheits- Krankenpflege und Sozialbereich entwickelt.
Wir bieten vier Qualifikationsstufen für die unterschiedlichen Bildungsbedürfnisse an.

Komplementäre Pflege – Aromapflege
→ Weiterbildung laut § 64 Abs. 3 GuKG
Diese 1-jährige berufsbegleitende Ausbildung richtet sich ausschlieslich an Angehörige des gehobenen Dienstes für Gesundheits- und Krankenpflege und ist im GuKG § 64 Abs. 3 geregelt. Sie schliest mit einer Facharbeit, einem mündlichen Prüfungsgespräch und der Verleihung des Zeugnisses ab. Nach erfolgreichem Abschluss darf die Zusatzbezeichnung „Komplementäre Pflege – Aromapflege“ geführt werden.
→ Siehe Seite 13 – 15
→ Fortbildungen laut § 63, § 104c GuKG
Im Basislehrgang Aromapflege und Aufbaulehrgang Aromapflege haben alle Pflegepersonen aus dem Gesundheits-, Krankenpflege-, Intensivpflege- und Sozialbereich sowie medizinisches Fachpersonal und pflegende Angehörige mit Aromapflege-Grundwissen die Möglichkeit, sich umfassend in der Aromapflege weiterzubilden. Die Lehrgange erfordern keine Facharbeit oder Prüfung. Sie enden innerhalb eines festgelegten Zeitrahmens, und die Teilnehmer erhalten ein Zeugnis, das die absolvierten Fortbildungsstunden bestatigt. → Siehe Seite 16 und 17
→ Fortbildungen laut § 63, § 104c GuKG
Unsere Fachseminare vermitteln allen Pflegepersonen, Pflegepädagogen als auch Mitarbeiter:innen im Gesundheits- und Sozialwesen sowie pflegenden Angehörigen theoretisches und praktisches Wissen, um die Aromapflege verantwortungsvoll und sicher im Berufsalltag einsetzen zu können. Nach Abschluss eines Aromapflege Fachseminars erhalt man eine Teilnahmebestätigung, auf der die Fortbildungsstunden vermerkt sind. → Siehe Seite 18 – 41
Nutze unsere regelmäßigen Kurzvorträge und Workshops in Wien sowie online, um Dir einen kompakten Eindruck von dem jeweiligen Fachseminar zu verschaffen. → Siehe Seite 52 und 53
Die Aromapflege hält seit Jahren Einzug in den Gesundheitsund Krankenpflegebereich und ist in vielen Krankenhäusern und Pflegeheimen bereits fester Bestandteil des professionellen Pflegealltags. Als anerkannte, komplementäre Pflegemethode ist die Aromapflege ein Teil der Pflanzenheilkunde und im Gesundheits- und Krankenpflegegesetz verankert. Sie beschäftigt sich mit der Anwendung von 100% naturreinen ätherischen Ölen, fetten Pflanzenölen, Hydrolaten und den daraus hergestellten Pflegeprodukten. Sie bietet beeindruckende Möglichkeiten: Die Anwendung und Wirkung erfolgt über den Geruchssinn, wie z. B. bei der Raumbeduftung, sowie über die intakte Haut, beispielsweise durch Waschungen, Hautpflege, Streichungen, Einreibungen, Wickel und Kompressen. Dabei dient die Aromapflege prophylaktischen und pflegerischen Maßnahmen und orientiert sich an den individuellen Bedürfnissen und Pflegeproblemen der jeweiligen Patient:innen. Die Aromapflege wird in den Pflegeprozess und in die dazugehörigen Pflegediagnosen integriert.
Mit unserer großen Ausbildung, unseren Lehrgängen und Fachseminaren bieten wir ALLEN Pflegepersonen verschiedene Qualifikationsstufen an, um sich entsprechend ihrer persönlichen und beruflichen Fortbildungsbedürfnisse in der Aromapflege weiterzubilden.
Unsere Kurzvorträge sind eine wunderbare Gelegenheit für Pflegepersonen, medizinisches Fachpersonal, pflegende Angehörige und Interessierte, sich einen ersten Überblick über unsere Fachseminare zu verschaffen. Ganz gleich, ob Du bereits Erfahrung mit Aromapflege hast oder neu in diesem Bereich bist – wir möchten Dir helfen, das für Dich passende Seminar zu finden.



→ Weiterbildung laut § 64 Abs. 3 GuKG
Die Aromapflege hat in den letzten Jahren unaufhaltsam Einzug in den Gesundheits- und Krankenpflegebereich gehalten. In vielen Krankenhäusern und Pflegeeinrichtungen ist sie als komplementäre Pflegemethode nicht mehr aus dem professionellen Pflegealltag wegzudenken.
Zahlreiche Forschungsteams widmen sich mittlerweile der Aufgabe, ätherischen Ölen immer neue Geheimnisse zu entlocken. Viele dieser Geheimnisse sind für uns in der Aromapflege jedoch keine großen Neuigkeiten mehr, sondern haben aufgrund unserer Erfahrung bereits einen festen Platz in unserem Pflegealltag gefunden. Doch dürfen wir uns auf diesen Erfolgen nicht ausruhen. Die Pflege durchläuft derzeit eine anspruchsvolle Umbruchs phase. Unsere Aufgabe ist es nun, die Aromapflege für die Zukunft zu rüsten und die Rahmenbedingungen für kommende Herausforderungen zu gestalten. Hierfür benötigen wir motivierte, engagierte und exzellent ausgebildete Aromapflegepersonen mit einem großen Herzen und einer feinen Nase!
Um das Netzwerk dieser Fachkräfte zu stärken, haben wir diese Weiterbildung ins Leben gerufen. Unser Ziel ist klar: Wir möchten neue Fortbildungsstandards für die Arbeit mit ätherischen Ölen, fetten Pflanzenölen und Hydrolaten in der Pflege setzen. Neben Evelyn DeutschGrasl, AE als Schulleiterin und Doris Kamleitner, BScN MA als Ausbildungsleiterin, wird Dich ein Team von hochkarätigen Referent:innen durch das Ausbildungsjahr führen – ganz nach dem Motto: „Von der Pflege, für die Pflege!“
Alle weiteren Informationen zu den Referent:innen, zur Anmeldung und zur gesetzlichen Grundlage der Ausbildung findest Du unter: www.aromapflege.com/ weiterbildung-komplementaere-pflege-aromapflege64-gukg-2025
UMFANG
242 Unterrichtseinheiten 12 Blöcke à 2,5 Tage (20 UE)
Datum 16.01.2025 bis 07.02.2026
INFOS
Referenten:innen
Evelyn Deutsch-Grasl, AE
Doris Kamleitner, BScN MA
Dr. in Gerda Dorfinger
Mag. a Andrea Gavanelli
Mag. Dr. Christian Gepart
Alicia Lanzerstorfer, BScN
Carmen Riegler
Mag. a Kathrin Sperker, MPH
Teilnehmer max 22 Personen
Zielgruppe ausschließlich Angehörige des gehobenen Dienstes für Gesundheits- und Krankenpflege
Gebühr
3.590,00 € (Ratenzahlung möglich) + 190,00 € Prüfungsgebühr
Ort
Wien & Tirol
Abschluss
Facharbeit, Zeugnis, Zusatzbezeichnung (Komplementäre Pflege - Aromapflege)
BLOCK 1
16. - 18.01.2025 (Do - Sa)
BLOCK 2
13. - 15.02.2025 (Do - Sa)
Aromapflege Basiswissen und allgemeine Grundlagen Was sind ätherische Öle, deren Gewinnungsmethoden, Aufnahmewege. Sicherheitsregeln und Vorsichtsmaßnahmen sowie hygienischer Umgang im Kontext mit ätherischen Ölen und aromapflegerischen Interventionen. Neurophysiologische Grundlagen des Geruchssinns. Dosierungen im Rahmen der aromapflegerischen Angebote.
Chemie der ätherischen Öle & Gültige Regeln für die Facharbeit Fundiertes, chemisch-praktisches Wissen über Inhaltsstoffe und deren Wirkung sowie möglichen Besonderheiten und Nebenwirkungen als Basis für eine verantwortungsvolle Arbeit mit ätherischen Ölen in der Pflegepraxis. Grundlagen zum Verfassen von schriftlichen Arbeiten/der schriftlichen Abschlussarbeit/Facharbeit.
BLOCK 3
20. -22.03.2025 (Do - Sa)
BLOCK 4
10. - 12.04.2025 (Do - Sa)
Rechtsgrundlagen, Implementierung, EBN und Pflegeplanung
Voraussetzungen und Rahmenbedingungen zur Implementierung von Aromapflege im klinischen Bereich sowie der häuslichen (extramuralen) Pflege. Evidenzbasierte Pflegepraxis und die Verbindung dieser mit den Schritten des Pflegeprozesses und deren Dokumentation. Rechtliche Grundlagen analog dem Gesundheits- und Krankenpflegegesetz im Kontext mit Aromapflege.
Monografien ätherischer Öle und fetter Pflanzenöle, Teil 1
Wissen zu ausgewählten grundlegenden ätherischen Ölen hinsichtlich Inhaltsstoffgruppen und deren Vertreter, Wirkweisen aus ganzheitlicher Sicht, Anwendungsmöglichkeiten sowie Besonderheiten und Kontraindikationen im Rahmen einer verantwortungsvollen Gesundheitspflege und -prävention. Einblicke in die Welt der fetten Pflanzenöle.
BLOCK 5
15. - 17.05.2025 (Do - Sa)
BLOCK 6
26. - 28.06.2025 (Do - Sa)
Botanik der Duft- und Heilpflanzen
Wissen um die botanischen Grundlagen der Duft- und Heilpflanzen, ordnen nach den zugehörigen Pflanzenfamilien und deren Besonderheiten, Grundlagen der Signaturenlehre, Exkursion in die Gärten des Schlossparks Schönbrunn (Zitruspflanzen).
Aromapflege Praxistage in Tirol
Dieser Block findet nicht in Wien, sondern in unserer Schule in Lechaschau statt. Eingebettet in die wunderbare Berglandschaft, werden wir hier die praktischen Anwendungsmöglichkeiten der Aromapflege, ganz losgelöst vom Alltagsstress, fühlen, spüren und erleben können - Raumbeduftung, Ölkompressen, feucht-heiße Kompressen, Streichungen, ätherische Öle als Wasch- und Badezusatz, Rosenwasserkompressen und Anwendung von Hydrolaten im Rahmen der Gesundheitspflege und Prävention, Anwendung von Pflegeölen für prophylaktische und pflege -
Ausbildung
rische Interventionen. Außerdem werden wir mit unserer Glasdestille die Gewinnung ätherischer Öle und Hydrolate live erleben können!
Monografien ätherischer Öle und fetter Pflanzenöle, Teil 2
Fortsetzung von Block 4. Wissen über Herstellungsmethoden von fetten Pflanzenölen, Qualitätskriterien und deren Inhaltsstoffe sowie Wirksamkeit, Integration der fetten Pflanzenöle im Rahmen der Gesundheitspflege und -prävention als wichtiger Teil der aromapflegerischen Praxis. Einblicke in die Welt der Pflanzenwässer (Hydrolate).
Grundkenntnisse zu wesentlichen Krankheitsbildern (Pathologie), Überblick Physiologie mit besonderem Fokus auf den Geruchssinn (Anatomie)
Grundkenntnisse zu anatomischen und physiologischen Vorgängen mit besonderem Fokus auf den Geruchssinn sowie pathophysiologischen Veränderungen im Rahmen des Lebenszyklus des Menschen. Ätherische Öle und deren neuroimmunologische und psychische Wirkung.
Aromapflege für die unterschiedlichsten Fachbereiche, Teil 1 Natürliche Hautpflege von Anbeginn, Begleitung der Entwicklung des Neugeborenen bis hin zur Pubertät, altersgerechte Unterstützung im Rahmen der Aromapflege bei Kinderkrankheiten und Wehwehchen des Alltags, bis hin zur speziellen Hautpflege im Teenageralter. Ätherische Öle und aromapflegerische Anwendungen als hilfreiche und ganzheitliche Unterstützung und Begleitung von Menschen mit akuten/ chronischen Schmerzen. Aromapflege um den letzten Lebensabschnitt, besonders würde- und liebevoll gestalten und mit einem Gefühl der Geborgenheit, begleiten zu können. Aromapflege im Kontext mit demenziell erkrankten Menschen.
Aromapflege für die unterschiedlichsten Fachbereiche, Teil 2 Ausgewählte prophylaktische Anwendungen im Rahmen von Verdauung, Atmung, Bewegung sowie zur Infektionsprophylaxe. Haut und Hautpflege im Rahmen des Lebenszyklus zur Stärkung der Hautgesundheit und des körpereigenen Immunsystems.
Wirkung ätherischer Öle und das Aromatogramm Studien und Wissenschaft über ätherische Öle und komplementäre Pflegeinterventionen, Erfahrungsberichte und ausgewählte Anwenderbeobachtungen sowie Untersuchungen aus dem Bereich der Aromapflege. Das Aromatogramm praxisnah und anschaulich vermittelt.
Präsentation der Facharbeit und Abschlussprüfung
Prüfungsvorbereitung und Kurzpräsentation der Facharbeit mit Feedback, sowie Abschlussprüfung und Verleihung der Zeugnisse.
BLOCK 7
04. - 06.09.2025 (Do - Sa)
BLOCK 8
09. - 11.10.2025 (Do - Sa)
BLOCK 9
06. - 08.11.2025 (Do - Sa)
BLOCK 10
11. - 13.12.2025 (Do - Sa)
BLOCK 11
08. - 10.01.2026 (Do - Sa)
BLOCK 12
05. - 07.02.2026 (Do - Sa)
I n houseSeminarmögl i c h G u KG
Fortbildungsstund e n 32
→ Fortbildung laut § 63, § 104c GuKG
UMFANG
32 Unterrichtseinheiten (UE)
4 Tage, jeweils 9:00 – 17:00 Uhr
TERMIN
siehe Seminare
INFOS
Referent:innen
Evelyn Deutsch-Grasl, AE
Carmen Riegler
Eva-Maria Rudorfer, BScN
Teilnehmer
max 20 Personen pro Seminar
Zielgruppe
Pflegepersonen aus dem Gesundheits-, Krankenpflege-, Intensivpflege- und Sozialbereich, Pflegepädagogen sowie medizinisches Fachpersonal. Auch für pflegende Angehörige geeignet. Kein Vorwissen notwendig.
Gebühr
558,00 € inkl. Seminarunterlagen, Arbeitsmaterial, Pausengetränke, Obst und Kekse
Ort
Wien & Tirol
Abschluss
Zeugnis
Basislehrgang Aromapflege
Dieser Lehrgang dient als Grundlage für alle Pflegepersonen, um die Aromapflege sicher und verantwortungsbewusst im Berufsalltag anwenden zu können.
Der Basislehrgang besteht aus zwei Seminaren: Aromapflege Einführung und Aromapflege Fortsetzung. Der Lehrgang stellt eine Fortbildung gemäß § 63 bzw. § 104c GuKG dar und erfordert keine Facharbeit oder Prüfung. Er schließt innerhalb des vorgegebenen Zeitrahmens mit dem Zeugnis Basislehrgang Aromapflege ab.
Nach Abschluss des Lehrgangs wird das Zeugnis auf Anfrage bei unserem Kundenservice per Post versendet. Es dient zugleich als Bestätigung der absolvierten Fortbildungsstunden für den Arbeitgeber.
Die Termine für die beiden Seminare sind im Seminarkatalog oder online zu finden und können separat gebucht werden. Beide Seminare können entweder als PräsenzSeminare oder als E-Learning-Seminare absolviert werden und müssen innerhalb eines Zeitrahmens von 12 Monaten abgeschlossen sein.
Vielen Dank für
die spannenden und lehrreichen Stunden.
Ich konnte viel Neues lernen, das mir sowohl beruflich als auch privat weiterhelfen wird.
JANA, DORNBIRN
→ Fortbildung laut § 63, § 104c GuKG
Dieser Lehrgang richtet sich an alle Pflegepersonen, die sich intensiv mit dem Thema Aromapflege auseinandersetzen möchten, einer Aromapflegegruppe angehören oder einen speziellen Fachbereich betreuen u.a.. Der Aufbaulehrgang knüpft an den Basislehrgang an und setzt zusätzlich die Teilnahme an den beiden Pflichtseminaren Aromapflege in der Praxis und Psychische Gesundheit fördern mit Aromapflege voraus. Darüber hinaus ist ein weiteres Seminar zu absolvieren, welches Du beliebig aus den unten aufgeführten Wahlseminaren auswählen kannst.
• Schmerz lass nach, 1 Tag, 8 UE
• So gelingt Aromapflege, 1 Tag, 8 UE
• Aromapflege bei Demenz, 1 Tag, 8 UE
• Aromapflege in der Palliative Care, 1 Tag, 8 UE
• Aromapflege im Wundmanagement, 1 Tag, 8 UE
• Aromatogramm, 1 Tag, 7 UE
• Riechtraining fürs Gehirn, 1 Tag, 8 UE
• Aromapflege und Recht, 1 Tag, 7 UE
• Aromapflege und die Wissenschaft, 1 Tag, 8 UE
Der Lehrgang ist eine Fortbildung laut § 63 bzw. § 104c GuKG und erfordert keine Facharbeit oder Prüfung. Er schließt innerhalb des vorgegebenen Zeitrahmens mit dem Zeugnis Aufbaulehrgang Aromapflege ab. Nach Abschluss des Lehrgangs wird das Zeugnis auf Anfrage bei unserem Kundenservice per Post versendet. Es dient zugleich als Bestätigung der absolvierten Fortbildungsstunden für den Arbeitgeber.
Die Termine für die Seminare sind im Seminarkatalog oder online zu finden und können separat gebucht werden. Der Aufbaulehrgang Aromapflege muss innerhalb eines Zeitrahmens von 24 Monaten abgeschlossen sein.
UMFANG
39+ Unterrichtseinheiten (UE), Tage und Dauer je nach Auswahl der Seminare
TERMIN
siehe ausgewählte Seminare
INFOS
Referent:innen
Evelyn Deutsch-Grasl, AE
Doris Kamleitner, BScN MA
Carmen Riegler
Dr. in Gerda Dorfinger
Mag. Dr. Christian Gepart
Eva-Maria Rudorfer, BScN
Maria Christina Margreiter, BScN
Esther Schauberger
Alicia Lanzerstorfer, BScN
Teilnehmer
max 20 Personen pro Seminar
Zielgruppe
Zeugnis Aufbaulehrgang Aromapflege G r undwissen erforderl i c h I n houseSeminarmögl i c h G u KGFortbildungsstund e n 39+
Pflegepersonen aus dem Gesundheits-, Krankenpflege-, Intensivpflege- und Sozialbereich sowie medizinisches Fachpersonal. Auch für pflegende Angehörige mit Aromapflege-Grundwissen geeignet.
Gebühr
ab 737,00 € inkl. Seminarunterlagen, Arbeitsmaterial, Pausengetränke, Obst und Kekse
Ort
Wien & Tirol
Abschluss
I n houseSeminarmögl i c h G u KGFortbildungsstund e n 16
Auch als E-Learning
Grundlagenwissen für die professionelle Aromapflege
→ Fortbildung laut § 63, § 104c GuKG
Die Aromapflege ist eine anerkannte, komplementäre Pflegemethode und Teil der Pflanzenheilkunde. Sie beschäftigt sich mit der Anwendung von 100% naturreinen ätherischen Ölen, fetten Pflanzenölen, Hydrolaten sowie den daraus hergestellten Pflegeprodukten und bietet uns eine Vielzahl an beeindruckenden Möglichkeiten. Die Anwendung und Wirkung erfolgt über den Geruchssinn (z.B. Raumbeduftung) und über die intakte Haut (z.B. Waschungen, Hautpflege, Streichungen, Einreibungen, Wickel und Kompressen).
Sie dient prophylaktischen und pflegerischen Maßnahmen, orientiert sich an den Bedürfnissen und individuellen Pflegeproblemen der jeweiligen Patient: innen und wird im Sinne des Pflegeprozesses sowie deren Pflegediagnosen integriert. Das Aromapflege Einführungsseminar ist die Grundlage für alle Pflegepersonen, um die Aromapflege verantwortungsvoll und sicher im Pflegealltag einsetzen zu können.

Evelyn Deutsch-Grasl, AE (Leitung der Schule) ist gelernte Drogistin, Diplomierte Gesundheits- und Krankenpflegerin, akademische Expertin für komplementäre Gesundheitspflege, geprüfte Aromatologin, Gesundheitsberaterin sowie erfahrene Heilkräuterfachfrau. Sie ist Gründerin und Leiterin unserer Gesundheitsschule und für die Einführung der Aromapflege in zahlreichen Kranken- und Pflegeeinrichtungen im Inund Ausland verantwortlich. Sie ist Autorin des Fachbuches „Aromapflege Handbuch - Leitfaden für den Einsatz ätherischer Öle im Gesundheits-, Krankenpflege und Sozialbereich“ und Vize-Präsidentin der Österreichischen Gesellschaft für wissenschaftliche Aromatherapie und Aromapflege (ÖGwA).
Theoretischer Teil
• Implementierung - was ist die Grundvoraussetzung für den Einsatz der Aromapflege in der Pflegepraxis?
• Was müssen wir zur Riechphysiologie wissen?
• Welche Sicherheitsregeln, Kontraindikationen und Vorsichtsmaßnahmen musst Du kennen?
• Was sind ätherische Öle, wie werden sie aufgenommen, wie werden sie gewonnen und welche Qualitätskriterien gibt es?
• Wir riechen, besprechen und erleben einige wichtige ätherische Öle
• Wir schauen uns die maßgeblichen Hydrolate und fetten Pflanzenöle an
Praktischer Teil
• Die richtige Dosierung kennen lernen
• Wie wird ein Hautverträglichkeitstest durchgeführt?
• Wir besprechen die maßgeblichen Anwendungsformen und probieren einige davon auch gleich aus: z.B. Raumbeduftung, Waschung, Fußbad, Kompressen mit Rosenhydrolat, Hautpflege, Einreibung, Streichung und Mundpflege
• Wir machen eine Entspannungsübung
• Wir besprechen zahlreiche Fallbeispiele für den beruflichen Alltag, die sich wunderbar auch in das Privatleben übertragen lassen
Ein wertvolles Seminar, das mir neue Impulse und Ideen gegeben hat.
JULIA, ST. PÖLTEN
TIROL
05. + 06.05.2025
Kurs-Nr. AE25-05-05
WIEN
10. + 11.02.2025
Kurs-Nr. AE25-02-10
02. + 03.04.2025
Kurs-Nr. AE25-04-02
09. + 10.09.2025
Kurs-Nr. AE25-09-09
19. + 20.11.2025
Kurs-Nr. AE25-11-19
GRAZ
27. + 28.02.2025
Kurs-Nr. AE25-02-27
INFOS
Referentin
Evelyn Deutsch-Grasl, AE + Eva-Maria Rudorfer, BScN
Dauer, Zeit
2 Tage, jew. 9.00 – 17.00 Uhr 16 Maßnahmenstunden
Teilnehmer
max 20 Personen
Zielgruppe
Pflegepersonen, medizinisches Fachpersonal und alle Interessierte
Gebühr
279,00 € inkl. Seminarunterlagen, Arbeitsmaterial, Pausengetränke, Obst und Kekse
G r undwissen erforderl i c h I n houseSeminarmögl i c h G u KGFortbildungsstund e n 16
TIROL
Auch als E-Learning
16. + 17.10.2025
Kurs-Nr. AF25-10-16
WIEN
05. + 06.03.2025
Kurs-Nr. AF25-03-05
20. + 21.05.2025
Kurs-Nr. AF25-05-20
30.09. + 01.10.2025
Kurs-Nr. AF25-10-30
03. + 04.12.2025
Kurs-Nr. AF25-12-03
Referentin
Evelyn Deutsch-Grasl, AE + Carmen Riegler
Dauer, Zeit
2 Tage, jew. 9.00 – 17.00 Uhr 16 Maßnahmenstunden
Teilnehmer
max 20 Personen
Zielgruppe
Pflegepersonen, medizinisches Fachpersonal und alle Interessierte mit Aromapflege-Grundwissen
Gebühr
279,00 € inkl. Seminarunterlagen, Arbeitsmaterial, Pausengetränke, Obst und Kekse

Vertiefungswissen für die professionelle Aromapflege
→ Fortbildung laut § 63, § 104c GuKG
Ziel der beiden Tage ist es, Dir ein tiefes Verständnis für die Wirkungsweise ätherischer Öle und deren verantwortungsvollen Einsatz in der Aromapflege zu vermitteln. Dazu werden wir uns unter anderem mit ätherischen Ölen als „Vielstoffgemisch“ eingehend beschäftigen. Wir empfehlen Dir, das Wissen aus dem Einführungsseminar gleich in die Praxis umzusetzen und ein paar Wochen die Aromapflege im Stationsalltag oder im Privatbereich zu erleben, bevor Du das Fortsetzungsseminar besuchst. Somit bringst Du bereits Erfahrungen und Fragen mit.
Theoretischer Teil
• Welche Möglichkeiten gibt es, die Qualität eines ätherischen Öles zu prüfen?
• Wie lange sind ätherische Öle und fette Pflanzenöle haltbar?
• Die Wirkungsweise ätherischer Öle aufgrund ihrer Zusammensetzung
• Das Aromatogramm - ein kurzer Einblick in die mikrobiologische Diagnostik mit ätherischen Ölen
Praktischer Teil
• Raumbeduftung ist viel mehr als nur ein guter Geruch
• Wir besprechen Wickel und Kompressen und probieren eine heiß-feuchte Dampfkompresse
• Wir machen eine Entspannungsübung
• Wir zeigen Dir ein professionelles Riechtraining
• Wir besprechen zahlreiche Fallbeispiele für den beruflichen Alltag, die sich wunderbar auch in das Privatleben übertragen lassen

Aufbau
Auffrischung, Optimierung und Vertiefung
→ Fortbildung laut § 63, § 104c GuKG
Diese beiden Praxistage erweitern Dein Wissen aus dem Einführungs- und Fortsetzungsseminar und es werden viele Fragen aus Deiner täglichen Arbeit mit der Aromapflege beantwortet. Wir werden viel riechen, fühlen und ausprobieren und werden die Gelegenheit haben, aromapflegerische Anwendungsformen hautnah und praktisch erleben zu können. Du wirst Wissen auffrischen und optimieren und viel Neues lernen. Besonders die Haut und die Hautfunktionen werden wir uns sehr genau anschauen und dadurch ein tiefes Verständnis für die Bedeutung einer natürlichen und gesunden Hautpflege erhalten.
Inhalte
• Wir besprechen die wichtigsten Grundregeln der Aromapflege und fassen die bekanntesten aromapflegerischen Anwendungsformen zusammen
• Wir schauen uns die Haut und die Hautfunktionen an und bekommen dadurch ein tiefes Verständnis für die Bedeutung einer natürlichen und gesunden Hautpflege
• Wir schauen uns die Wirkungsweisen der Aromapflege praxisnah anhand von Erfahrungsberichten und Anwenderbeobachtungen an
• Wir machen zahlreiche praxisorientierte Anwendungen und Entspannungsübungen, für den beruflichen Alltag, die sich wunderbar auch in das Privatleben übertragen lassen
• Wir tauschen unsere Erfahrungen aus und erarbeiten Antworten auf Ihre Fragen aus der täglichen Praxis
TIROL
06. + 07.11.2025
Kurs-Nr. AP25-11-06
WIEN
02. + 03.06.2025
Kurs-Nr. AP25-06-02
16. + 17.12.2025
Kurs-Nr. AP25-12-16
INFOS
Referentin
Evelyn Deutsch-Grasl, AE + Carmen Riegler
Dauer, Zeit
2 Tage, jew. 9.00 – 17.00 Uhr 16 Maßnahmenstunden
Teilnehmer max 20 Personen
Zielgruppe
Pflegepersonen, medizinisches Fachpersonal und alle Interessierte mit Aromapflege-Grundwissen
Gebühr
279,00 € inkl. Seminarunterlagen, Arbeitsmaterial, Pausengetränke, Obst und Kekse



Wunderwerk Nase
Maria Christina Margreiter, Evelyn Deutsch-Grasl
Alles über den unterschätzten Sinn - das Riechen und wie man ihn trainieren kann
Lassen Sie sich beim Lesen dieses Buches in die verborgenen Tiefen eines oft unterschätzten Sinnes – des Geruchssinnes – entführen.
1. Auflage 2024, 192 Seiten, broschiert, Aromapflege Verlag
Evelyn Deutsch-Grasl, Bärbl Buchmayr, Marlene Fink
Leitfaden für den Einsatz ätherischer Öle im Gesundheits-, Krankenpflege- und Sozialbereich
5. Auflage 2023, 308 Seiten, broschiert, Aromapflege Verlag
45,90 €


Eliane Zimmermann
Mit dieser erweiterten Auflage möchte Eliane Zimmermann die Hydrolate aus dem Schattendasein der Aromatherapie und Aromapflege herausholen und deren beeindruckenden Möglichkeiten aufzeigen. Ihrem Steckenpferd Studien hat Eliane Zimmermann diesmal ein eigenes Kapitel gewidmet.
2. Auflage 2018, 134 Seiten, broschiert, Aromapflege Verlag
29,90 €
Aufbau
Wie Pflegepersonen Patient:innen mit psychiatrischen Krankheitsbildern unterstützen und sich selbst stärken können
→ Fortbildung laut § 63, § 104c GuKG
In unserer Leistungsgesellschaft gibt es viele psychiatrische Erkrankungen der Patient:innen, die auf Stationen wie z.B. Unfallchirurgie, Gynäkologie, usw. oder auf Ambulanzen, eine ganz spezielle Herausforderung für die Pflegepersonen darstellen. Neben der „klassischen Pflege“ bietet die „Psycho-Aromapflege“ als komplementäre Pflegemethode einerseits für Patient:innen mit unterschiedlichsten psychiatrischen Krankheitsbildern und andererseits den damit konfrontierten Pflegekräften, einen wichtigen unterstützenden Baustein zur Gesundheitsförderung! Dieses Seminar zeigt auf, wie ätherische Öle die Psyche positiv beeinflussen, Entlastung fördern und ein positives Umfeld schaffen können.
Inhalte
• Eine Einführung in die psychiatrische Pflege
• Pflegerisches Selbstverständnis im Umgang mit Patient:innen/Bewohner:innen mit psychiatrischen Erkrankungen
• Duft und Wahrnehmung – neurobiologische Grundlagen
• Neurotransmitter – Unterschied zwischen beruhigenden und aktivierenden Botenstoffen, wie ätherische Öle diese beeinflussen
• Psychische Erkrankungen – eine Übersicht der Krankheitsbilder (Ängste, Depressionen, Burnout)
• Praxisbeispiele und wie Aromapflege eingesetzt wird
• Auswahl ätherischer Öle und deren Dosierung
• Fallbeispiele und Übungen – Duftreise, Selbstmassage der Hände
WIEN
13. + 14.05.2025
Kurs-Nr. PG25-05-13
12. + 13.11.2025
Kurs-Nr. PG25-11-12
INFOS
Referentin
Carmen Riegler
Dauer, Zeit
2 Tage, jew. 9.00 – 17.00 Uhr 16 Maßnahmenstunden
Teilnehmer max 20 Personen
Zielgruppe
Pflegepersonen, medizinisches Fachpersonal und alle Interessierte mit Aromapflege-Grundwissen
Gebühr
279,00 € inkl. Seminarunterlagen, Arbeitsmaterial, Pausengetränke, Obst und Kekse
Carmen Riegler ist Diplomierte Psychiatrische Gesundheits- und Krankenpflegerin und Absolventin der Weiterbildung Komplementäre Pflege - Aromapflege laut § 64 GuKG mit 17 Jahren Berufserfahrung. Sie hat die Aromapflege im Therapiezentrum Ybbs aufgebaut und implementiert und ist seit 2021 als Fachreferentin zum Thema Aromapflege bzw. Assistenz der Schulleitung bei uns tätig.

G r undwissen erforderl i c h I n houseSeminarmögl i c h G u KGFortbildungsstund e n 8
Web-Seminar
WIEN
09.05.2025
Kurs-Nr. SZ25-05-09
07.10.2025
Kurs-Nr. SZ25-10-07
WEB-SEMINAR
28.03.2025
Kurs-Nr. SZ25-03-28
INFOS
Referentin
Esther Schauberger
Dauer, Zeit
1 Tag, 9.00 – 17.00 Uhr 8 Maßnahmenstunden
Teilnehmer
max 20 Personen
Zielgruppe
Pflegepersonen, medizinisches Fachpersonal und alle Interessierte mit Aromapflege-Grundwissen
Gebühr
179,00 € inkl. Seminarunterlagen, Arbeitsmaterial, Pausengetränke, Obst und Kekse. Bei Buchung WebSeminar inkl. Seminarpaket mit Seminarunterlagen und Arbeitsmaterial (per Post)

Aromapflege als wertvolle Ergänzung bei der pflegerischen Betreuung von Schmerzpatient:innen
→ Fortbildung laut § 63, § 104c GuKG
Das Seminar wird Dir helfen, die Schmerzthematik besser zu verstehen. Zahlreiche wissenschaftliche Untersuchungen zeigen, dass die erfolgreiche Behandlung und Linderung von Schmerzen einem breit gefächerten Ansatz, welcher nicht nur im medizinisch-medikamentösen Bereich zu finden ist, unterliegt. So vielfältig die Ursachen für Schmerzen sind - genauso unterschiedlich gestalten sich die Möglichkeiten zur Linderung bzw. Beseitigung und setzen eine enge Zusammenarbeit von unterschiedlichen Berufsgruppen im Gesundheitsbereich voraus. In diesem Zusammenhang kann die Aromapflege zur Linderung von Beschwerden und Verbesserung des Wohlbefindens von akuten und chronischen Schmerzpatient*innen im häuslichen wie auch stationären Bereich beitragen.
Inhalte
• Wie entsteht Schmerz, wie wird er weitergeleitet und wahrgenommen?
• Welche Schmerzarten und Schmerzformen gibt es?
• Wichtige komplementäre pflegerische Möglichkeiten zur Schmerzlinderung im Überblick
• Nebenwirkungsmanagement - wie wir mit Aromapflege medikamentöse Schmerztherapien begleiten können
• Welche Wirkmechanismen machen ätherische Öle, fette Pflanzenöle und Hydrolate zu einem hilfreichen Begleiter?
• Best Practice: Bewährte Produkte und deren praktische Anwendung
Esther Schauberger ist seit 2003 als Diplomierte Psychiatrische Gesundheits- und Krankenpflegerin tätig. Sie hat Weiterbildungen in Aromapflege, Therapeutic Touch und Schmerzmanagement (alle nach § 64 GuKG) absolviert. Ab 2017 bis Anfang 2023 war sie im Therapiezentrum Ybbs als Pflegeexpertin für komplementäre Pflege tätig. Derzeit studiert sie ANP und Gesundheits- und Pflegepädagogik an der Universität für Weiterbildung Krems und mit März 2023 erfolgte der Wechsel als Lehrende für Gesundheits- und Krankenpflege an den Campus Favoriten (Wiener Gesundheitsverbund).
Aufbau
Mit den richtigen Kniffen zielführend umsetzen
→ Fortbildung laut § 63, § 104c GuKG
Du lernst Schritt für Schritt die erforderlichen Maßnahmen kennen, um die Aromapflege erfolgreich in den Pflegealltag integrieren zu können. Dieser Prozess stellt oft eine Hürde dar, da Pflegepersonen mit einer Vielzahl von Aufgaben konfrontiert sind. Pflegehandlungen müssen kritisch denkend geplant werden, der aktuelle Stand der Pflegewissenschaft muss im Auge behalten werden, die Pflegeforschung soll durch Initiierung von Projekten vorangetrieben werden und relevante Ergebnisse sollen in den Pflegealltag integriert und evaluiert werden. Mit dem richtigen Ansatz ist es einfach und überaus spannend, Pflegeprozess, Pflegedokumentation und Entscheidungsfindung sinnvoll ineinandergreifen zu lassen. Mit diesem Seminar konnten wir schon vielen Pflegepersonen die Scheu nehmen, sich diesem Thema professionell zu widmen. Die Pflegedokumentation wird oft nur als notwendiges Übel gesehen. Dabei ist sie der Schlüssel zu wertvollen Erkenntnissen und eine wichtige Basis, um die Aromapflege weiterzuentwickeln.
Inhalte
• Welche Fachbegriffe sind für Dich wichtig?
• Du erhältst eine Schritt-für-Schritt-Anleitung
• Du wirst die Säulen der Entscheidungsfindung kennen lernen
• Wir zeigen Dir, wie Du die Aromapflege in den Pflegeprozess integrieren kannst
• Du erhältst das Rüstzeug und die Kriterien, um die Gestaltung von Anwenderbeobachtungen durchführen zu können
G u KGFortbildungsstund e n 8 Hybrid-Sminar
WIEN
25.09.2025
Kurs-Nr. IM25-09-25
HYBRID-SEMINAR
25.09.2025
IKurs-Nr. IMHY25-09-25
INFOS
Referentin
Doris Kamleitner, BScN MA
Dauer, Zeit
1 Tag, 9.00 – 17.00 Uhr 8 Maßnahmenstunden
Teilnehmer max 20 Personen
Zielgruppe Fachpersonal
Gebühr
179,00 € inkl. Seminarunterlagen, Arbeitsmaterial, Pausengetränke, Obst und Kekse. Bei Buchung Hybrid-Seminar inkl. Seminarpaket mit Seminarunterlagen (per Post)
Doris Kamleitner, BScN MA (Leitung der Weiterbildung) bringt in unser Team die pflegewissenschaftliche Komponente mit ein. Sie ist Diplomierte Gesundheits- und Krankenpflegeperson, Absolventin des Masterstudiums Pflegewissenschaft, Absolventin der Weiterbildung Komplementäre Pflege - Aromapflege laut § 64 GuKG; tätig als Referentin in der AUVA Hauptstelle - Medizinische Direktion – Pflegekoordination, wo sie allen AUVA Einrichtungen im Bereich Pflegedokumentation, EBN sowie Aromapflege unterstützend zur Seite steht.




Aufbau
Düfte als Schlüsselreize in der Pflege von demenziell erkrankten Menschen
→ Fortbildung laut § 63, § 104c GuKG
Erinnerungen sind ein Schatz unserer Vergangenheit. Sie laden uns zum Innehalten und Verweilen ein, tun gut und ermöglichen uns unseren Lebensspuren nachzugehen. Düfte prägen von Geburt an unser Leben, fördern unsere Entwicklung und schaffen Geborgenheit. Vor allem in der Altenpflege kann das Wachrufen von Erinnerungen mit Düften die aromapflegerische Arbeit bereichern.
Du lernst belastende Situationen wie den veränderten Tag-Nacht-Rhythmus, Agitation, Ängste und den damit verbundenen Stress, sowohl für die betroffenen Menschen als auch ihre Betreuungspersonen zu lindern und sogar zu verhindern. Wir erarbeiten aromapflegerische Möglichkeiten, die sich an den Grundsätzen der basalen Stimulation, dem Leibgedächtnis und der Berücksichtigung der Körper- und Umweltsinne orientieren und schauen uns Konzepte wie die 10-MinutenAktivierung, Snoezelen oder die Validation an.
Inhalte
• Wie kannst Du Düfte als Schlüsselreize wirkungsvoll zur Biografiearbeit und Erinnerungspflege einsetzen?
• Welche Einsatzmöglichkeiten bieten Dir ätherische Öle bei den drei A´s der dementiellen Erkrankung: Angst, Agitation (Unruhe) und Aggression?
• Wie kannst Du mit einer gesunden Lebensweise Demenz vorbeugen?
• Best Practice: wir erstellen eine persönliche Duftbiografie, wir führen ein Riechtraining durch und erarbeiten für die häufigsten Problemstellungen aromapflegerische Lösungsansätze
Auch als E-Learning
Carmen Riegler + Eva-Maria Rudorfer, BScN
WIEN
13.03.2025
Kurs-Nr. DM25-03-13
04.11.2025
Kurs-Nr. DM25-11-04
GRAZ
06.06.2025
Kurs-Nr. DM25-06-06
10.10.2025
Kurs-Nr. DM25-10-10
INFOS
Referentin
Carmen Riegler + Eva-Maria Rudorfer, BScN
Dauer, Zeit
1 Tag, 9.00 – 17.00 Uhr 8 Maßnahmenstunden
Teilnehmer max 20 Personen
Zielgruppe
Pflegepersonen, medizinisches Fachpersonal und alle Interessierte mit Aromapflege-Grundwissen
Gebühr
179,00 € inkl. Seminarunterlagen, Arbeitsmaterial, Pausengetränke, Obst und Kekse


G r undwissen erforderl i c h I n houseSeminarmögl i c h G u KGFortbildungsstund e n 8
Web-Seminar
WIEN
28.04.2025
Kurs-Nr. PC25-04-28
17.11.2025
Kurs-Nr. PC25-11-17
WEB-SEMINAR
20.02.2025
Kurs-Nr. PC25-06-04
GRAZ
04.06.2025
Kurs-Nr. PC25-00-00
06.11.2025
Kurs-Nr. PC25-11-06
INFOS
Referentin
Alicia Lanzerstorfer, BScN + Eva-Maria Rudorfer, BScN
Dauer, Zeit
1 Tag, 9.00 – 17.00 Uhr 8 Maßnahmenstunden
Teilnehmer max 20 Personen
Zielgruppe
Pflegepersonen, medizinisches Fachpersonal und alle Interessierte mit Aromapflege-Grundwissen
Gebühr
179,00 € inkl. Seminarunterlagen, Arbeitsmaterial, Pausengetränke, Obst und Kekse

Wertvolle Unterstützung bei der Begleitung von Menschen im letzten Lebensabschnitt → Fortbildung laut § 63, § 104c GuKG
Die Verbesserung der Lebensqualität ist eine zentrale Aufgabe in der Palliative Care. Aromapflege ist bei der Pflege schwerstkranker und sterbender Menschen, sowie bei der Begleitung ihrer Angehörigen ein unverzichtbarer Teil eines ganzheitlichen Pflegekonzeptes. Durch den gezielten und individuellen Einsatz aromapflegerischer Maßnahmen, gelingt es häufig Erleichterung und Geborgenheit zu vermitteln. Die Aromapflege bietet uns eine wertvolle Möglichkeit, die betroffenen Menschen mit ihren Vorlieben, Abneigungen, Gefühlen und Ängsten in den Mittelpunkt zu stellen. Wir lernen unter Einsatz von ätherischen Ölen den letzten Lebensabschnitt besonders würde- und liebevoll zu gestalten und zu begleiten, um den Patient:innen ein Höchstmaß an Lebensqualität bieten zu können
Inhalte
• Vorstellung aromapflegerischer Möglichkeiten
• Unterstützende aromapflegerische Maßnahmen, orientiert an den häufigsten Symptomen
• Wir besprechen die Sterbephasen nach Elisabeth Kübler-Ross und lernen dazu eine entsprechende Auswahl ätherischer Öle kennen
• Wir stellen eine Reihe aromapflegerischer Möglichkeiten zur Verbesserung der Lebensqualität und Förderung des Wohlbefindens vor
• Best Practice: Fallbeispiele und Übungen
Bei Buchung Web-Seminar inkl. Seminarpaket mit Seminarunterlagen und Arbeitsmaterial (per Post)
Alicia Lanzerstorfer, BScN ist Diplomierte Gesundheits- und Krankenpflegerin. Absolventin der Weiterbildung Komplementäre Pflege - Aromapflege laut § 64 GuKG. Absolventin der Weiterbildung Interprofessioneller Basislehrgang Palliative Care. Implementierung von Aromapflege und Leitung der Arbeitsgruppe Aromapflege am Klinikum Wels - Grieskirchen. Dort war sie fast 10 Jahre auf der Palliativstation, inzwischen arbeitet sie auf der Station für Lungenheilkunde. Seit 2016 Referentin zum Thema Aromapflege.
Gesundheitspflege zur Bewahrung der intakten Haut
→ Fortbildung laut § 63, § 104c GuKG
In diesem praxisnahen Seminar erlernst Du den Einsatz von Aromapflege und speziellen Produkten für ein wirksames Wundmanagement, um die Hautgesundheit zu fördern und verbessern. Du erhältst Einblick in die Vorbeugung und wie man das Rezidiv Risiko von Erkrankungen wie Ulcus cruris, Inkontinenz- assoziierter Dermatitis, Dekubitus und spezifischen Hautproblemen bei Diabetikern, wie das diabetische Fußsyndrom, minimieren kann. Das Seminar hebt die Bedeutung der Aromapflege für die Hautintegrität und das Wohlbefinden hervor und legt den Fokus auf eine umfassende Betrachtung der Hautpflege. Es bietet Dir praktische Werkzeuge für die Patientenedukation und für direkte Pflegemaßnahmen, um langfristig die Hautgesundheit zu unterstützen.
Inhalte
• Vom Wunder der Zelle bis zum Wunderwerk Mensch, für ein tieferes Verständnis der ganzheitlichen Hautpflege
• Die Ernährungsrelevanz in Prophylaxe/Heilung chronischer Wunden
• Die Bedürfnisse der Haut bei chronisch venöser Insuffizienz, peripherer arterieller Verschlusskrankheit und diabetischem Fußsyndrom
• Aromapflege: Bedeutung, Einsatz und Grenzen in der chronischen (palliativen) Wundversorgung
• Aromapflege bei Strahlentherapie für Hautpflege und Wohlbefinden
• Fallbeispiele und Patientenedukationstipps
WIEN
11.03.2025
Kurs-Nr. WM25-03-11
21.10.2025
Kurs-Nr. WM25-10-21
GRAZ
10.04.2025
Kurs-Nr. WM25-04-10
09.10.2025
Kurs-Nr. WM25-10-09
INFOS
Referentin
Eva-Maria Rudorfer, BScN
Dauer, Zeit
1 Tag, 9.00 – 17.00 Uhr 8 Maßnahmenstunden
Teilnehmer max 20 Personen
Zielgruppe
Fachpersonal mit Aromapflege Grundwissen, sowie in bereits Wundmanagement ausgebildete Pflegepersonen
Gebühr
179,00 € inkl. Seminarunterlagen, Arbeitsmaterial, Pausengetränke, Obst und Kekse
Eva-Maria Rudorfer, BScN ist Diplomierte Gesundheits- und Krankenpflegeperson mit 16 Jahren Berufserfahrung. Absolventin der Weiterbildung Komplementäre Pflege-Aromapflege und Wundmanagement (nach § 64 GuKG); hat einen universitären Abschluss in Pflegewissenschaft und langjährige Erfahrung als Fachreferentin zum Thema Aromapflege. Ist als Pflegeberaterin tätig und absolviert derzeit den Masterstudiengang ANP an der PMU Salzburg.

Aufbau
Mikrobiologische Diagnostik mit ätherischen Ölen
→ Fortbildung laut § 63, § 104c GuKG
Ätherische Öle sind für Pflanzen wirksame und lebenswichtige chemische Waffen zur Abwehr von Infektionen mit Erregern, wie Bakterien, Pilzen oder Viren. Die Aromapflege und Aromatherapie machen sich diese Schutzwirkung zunutze. Die Wirksamkeit der einzelnen ätherischen Öle gegen bestimmte Keime kann im Labor mit einem Aromatogramm oder Reihenverdünnungstest untersucht werden. Diese Untersuchungsmethode bietet uns die Möglichkeit, die jeweils wirksamsten ätherischen Öle herauszufiltern, um diese ganz gezielt zur Infektionsbehandlung und Prophylaxe einsetzen zu können. Du erlebst das Aromatogramm, die damit verbundenen Möglichkeiten und die mikrobiologische Arbeit hautnah im aufgebauten „Seminarlabor“ mit!
Inhalte
• Die Grundbegriffe der Bakteriologie
• Welche Kulturmethoden gibt es?
• Das Aromatogramm und der Reihenverdünnungstest
• Wie wirken ätherische Öle auf verschiedene Keime?
• Spezielle Tipps für typische Krankenhauskeime
• Welche Anwendungsformen stehen uns zur Verfügung?
• Best Practice: Anwendungsbeispiele ätherischer Öle bei Harnwegsinfekten im Selbstversuch
G r undwissen erforderl i c h G u KGFortbildungsstund e n 7
WIEN
04.10.2025
Kurs-Nr. AR25-10-04
INFOS
Referentin
Dr. in Gerda Dorfinger
Dauer, Zeit
1 Tag, 9.00 – 16.00 Uhr
7 Maßnahmenstunden
Teilnehmer
max 20 Personen
Zielgruppe
Pflegepersonen, medizinisches Fachpersonal und alle Interessierte mit Aromapflege-Grundwissen
Gebühr
179,00 € inkl. Seminarunterlagen, Arbeitsmaterial, Pausengetränke, Obst und Kekse
Dr.in Gerda Dorfinger ist Fachärztin für Medizinische und Chemische Labordiagnostik und Fachärztin für Zytodiagnostik. Sie ist Wahlärztin in Wien in einer Praxisgemeinschaft. Seit vielen Jahren beschäftigt sie sich mit dem Einsatz ätherischer Öle bei Infekten und ist Teil des Lehrgangsteams „Medizinische Aromatherapie“. Als Spitalsärztin ist sie Oberärztin im Zentrallabor der Klinik Ottakring, übt eine Lehrtätigkeit auf der Donau-Universität Krems sowie am FH Campus Wien aus und ist Präsidentin der ÖGwA.

G u KGFortbildungsstund e n 7
Aufbau
Überlegungen zu mehr Rechtssicherheit in der Aromapflege
→ Fortbildung laut § 63, § 104c GuKG
24.04.2025
Kurs-Nr. RE25-04-24
INFOS
Referent
Mag. Dr. Christian Gepart
Dauer, Zeit 1 Tag, 9.00 – 16.00 Uhr 7 Maßnahmenstunden
Teilnehmer max 20 Personen
Zielgruppe
Fachpersonal
Gebühr
179,00 € inkl. Seminarunterlagen, Arbeitsmaterial, Pausengetränke, Obst und Kekse
Maßnahmen der Aromaanwendungen gelten im Sinne der gesundheitsrechtlichen Terminologie als komplementäre Anwendungen zu etablierten Vorgehensweisen im Bereich der pflegerischen Kernkompetenzen sowie bei medizinisch-diagnostischen und medizinisch-therapeutischen Kompetenzen. Bei der Festlegung, Durchführung und Evaluation von Maßnahmen der Aromatherapie sowie der Aromapflege besteht eine strenge Bindung an die berufsgesetzlich normierten Berufspflichten, Berufsbilder sowie Kompetenz- und Handlungsbereiche.
Inhalte
• Aromapflege als Teil der Berufsbilder in der Gesundheits- und Krankenpflege
• Grundlegende Aspekte der Berufspflichten und Kompetenzen in der Gesundheits- und Krankenpflege
• Spezielle Anwendungsfragen bei der Aromapflege
• Bildungsaspekte (Ausbildung-FortbildungWeiterbildung)
• Abgrenzung „Aromapflege - Gewerberecht“
• Diskussion ausgewählter Praxisbeispiele mit rechtlicher Relevanz

Mag. Dr. Christian Gepart übte mehrere Jahre den Beruf des diplomierten Gesundheits- und Krankenpflegers aus und ist heute Rechtsanwalt in Wien mit den Tätigkeitsschwerpunkten Gesundheits-, Arbeits- und Haftungsrecht. Er ist Lehrender an mehreren Fachhochschulen (insbesondere Fachhochschule Wiener Neustadt und IMC Fachhochschule Krems) und ständiges Redaktionsmitglied der Österreichischen Zeitschrift für Pflegerecht.
Relevante Studien finden, bewerten und anwenden
→ Fortbildung laut § 63, § 104c GuKG
Spricht man über Aromapflege hört man immer wieder, dass es nur wenige Studien gäbe. Aber allein in der Datenbank PubMed® sind in den letzten zehn Jahren über 200 Studien zu diesem Thema erschienen. Doch nicht alles, was im Internet zu finden ist, ist tatsächlich eine Studie von guter Qualität mit aussagekräftigen Ergebnissen. Was zeichnet eine gute Studie aus? Wie finde ich diese? Und wie kann ich gute Studien für meine Arbeit mit Aromapflege einsetzen?
Um sich auf dem Gebiet der Aromapflege über neueste wissenschaftliche Erkenntnisse zu informieren und folglich fortbilden zu können, lernst Du in diesem Seminar, nach relevanten Studien zu recherchieren und diese zu bewerten. Du weißt am Ende außerdem, wie man eine Anwenderbeobachtung durchführt und kannst so Deine erste „kleine Studie“ ausprobieren.
Inhalte
• Fachbegriffe kennenlernen und richtig einordnen
• Nach aromapflegerischen Studien recherchierenSchritte der Literaturrecherche
• Studien lesen und bewerten - Du erhältst verständliche Kriterien
• Die Sprache der Studien: mit ein paar Klicks vom Englischen ins Deutsche übersetzen
• Anwenderbeobachtungen kennenlernen - Du erhältst das Rüstzeug, um selbst eine durchzuführen
G r undwissen erforderl i c h G u KGFortbildungsstund e n 8
WIEN
23.10.2025
Kurs-Nr. AW25-10-23
HYBRID-SEMINAR
23.10.2025
Kurs-Nr. AWHY25-10-23
INFOS
Referentin
Hybrid-Sminar
Doris Kamleitner, BScN MA
Dauer, Zeit
1 Tag, 9.00 – 17.00 Uhr 8 Maßnahmenstunden
Teilnehmer max 20 Personen
Zielgruppe
Pflegepersonen, medizinisches Fachpersonal und alle Interessierte mit Aromapflege-Grundwissen
Gebühr
179,00 € inkl. Seminarunterlagen, Arbeitsmaterial, Pausengetränke, Obst und Kekse. Bei Buchung Hybrid-Seminar inkl. Seminarpaket mit Seminarunterlagen (per Post)
Doris Kamleitner, BScN MA (Leitung der Weiterbildung) bringt in unser Team die pflegewissenschaftliche Komponente mit ein. Sie ist Diplomierte Gesundheits- und Krankenpflegeperson, Absolventin des Masterstudiums Pflegewissenschaft, Absolventin der Weiterbildung Komplementäre Pflege - Aromapflege laut § 64 GuKG; tätig als Referentin in der AUVA Hauptstelle - Medizinische Direktion – Pflegekoordination, wo sie allen AUVA Einrichtungen im Bereich Pflegedokumentation, EBN sowie Aromapflege unterstützend zur Seite steht.

Geruchssinn trainieren mit Düften und Fachbuch
Das Set enthält:
• 4 ätherische Öle
• 4 Riechstifte aus Glas/Alu
• 1 Riechstreifenblock
• 1 Ratgeber Riechtraining
• 4 Duft-Memory Karten
• Anleitung für Einzel- oder Gruppenanwendung
• 1 Trainingsplan
• Fachbuch „Wunderwerk Nase“
Ein gezieltes Riechtraining kann viele positive Effekte haben:
• die Fähigkeit zum Riechen verbessern
• als Frühwarnzeichen für neurodegenerative Erkrankungen
• Denkprozesse von z.B. Senioren aktiv anregen
• Konzentration und Leistungsfähigkeit steigern
• als „Frischzellenkur“ für das Gehirn fungieren
• die Lebensqualität steigern
• als regelmäßiges Gedächtnistraining
1 Set SET19-11
89,00 €

aromapflege.com/ riechtraining-set-mit-wunderwerk-nase

Aufbau
Wie ätherische Öle bei Geruchsverlust unterstützen
→ Fortbildung laut § 63, § 104c GuKG
Wenn unser Geruchssinn beeinträchtigt ist, sind wir in der Wahrnehmung von Gefahren, in der interpersonellen Kommunikation, sowie beim Essen und Trinken deutlich eingeschränkt. Riechstörungen sind bei Patient:innen mit neurodegenerativen Krankheitsbildern, wie AlzheimerDemenz oder Morbus Parkinson, häufig das Frühsymptom. Zahlreiche wissenschaftliche Untersuchungen zeigen, dass durch die regelmäßige Stimulierung des Riechorgans ein Wachstum der Riechzellen und folglich eine Verbesserung des Geruchssinns und Aktivierung bestimmter Teile des Gehirns erzielt werden kann. Du lernst alltagstaugliche Möglichkeiten für die Umsetzung eines Riechtrainings kennen, sowie die ätherischen Öle, die sich besonders dafür anbieten.
Inhalte
• Von Riechzellen und Rezeptoren - Wunderwerk Nase
• Veränderungen des Geruchssinnes
• Geruchlos durchs Leben - Folgen von Riechstörungen
• Ätherische Öle als Trainingsduftstoffe
• Best Practice: Von prophylaktischen Riechübungen zum spezifischen Training von Nase und Gehirn mit dem Aromapflege Riechtraining Set
Veranstaltungstipp:
Lesung aus dem Buch „Wunderwerk Nase“ mit der Autorin Maria Christina Margreiter 24. Oktober 2024, 19.00 Uhr, Schule Tirol 14. November 2024, 19.00 Uhr, Schule Wien Anmeldung unter +43 5672 64942 oder info@aromapflege.com
WIEN
31.01.2025
Kurs-Nr. BG25-01-31
INFOS
Referentin
Maria Christina Margreiter, BScN
Dauer, Zeit
1 Tag, 9.00 – 17.00 Uhr
8 Maßnahmenstunden
Teilnehmer
max 20 Personen
Zielgruppe
Pflegepersonen, medizinisches Fachpersonal und alle Interessierte mit Aromapflege-Grundwissen
Gebühr
179,00 € inkl. Seminarunterlagen, Arbeitsmaterial, Pausengetränke, Obst und Kekse
Maria Christina Margreiter, BScN ist Diplomierte Gesundheits- und Krankenpflegerin. Vom Beginn ihrer Berufslaufbahn an gehören neurologische Krankheitsbilder zu ihren besonderen Interessen. So arbeitete sie sieben Jahre auf einer Akut - Neurologie und anschließend in einem Rehazentrum für Querschnittpatient*innen. Weiters unterrichtete sie nach ihrem Studium der Pflegewissenschaft (Schwerpunkt Pädagogik) an einer Gesundheits- und Krankenpflegeschule. Sie ist Absolventin der Weiterbildung Komplementäre Pflege - Aromapflege laut § 64 GuKG. Derzeit ist sie als Community Nurse tätig.

G u KGFortbildungsstund e n 8 I n houseSeminarmögl i c h
WIEN
14.03.2025
Kurs-Nr. AO25-03-14
14.11.2025
Kurs-Nr. AO25-11-14
INFOS
Referentin
Carmen Riegler
Dauer, Zeit
1 Tag, 9.00 – 17.00 Uhr 8 Maßnahmenstunden
Teilnehmer
max 22 Personen
Zielgruppe
Ordinationsassistent:innen, Pflegepersonal, Ordinationshilfe, Sprechstundenhilfe – Medizinische Verwaltungsassistenz, Praxismitarbeiter:innen, Ordinationsmanager:innen
Gebühr
179,00 € inkl. Seminarunterlagen, Arbeitsmaterial, Pausengetränke, Obst und Kekse
Neue Wege und Aspekte für diesen Praxisbereich
→ Fortbildung laut § 63, § 104c GuKG
Fortbildung laut § 13 (2) MAB-Gesetz
Im Ordinations- und Ambulanzalltag stehst Du im direkten Kontakt zu den Patient:innen. Die Aromapflege bietet Dir in diesem speziellen Bereich wertvolle Hilfsmittel, die Du auch zur Selbstfürsorge einsetzen kannst.
In dieser Fortbildung lernst Du praxisnah, welche ätherischen Öle zum Beispiel bei Ängsten, Nervosität oder Übelkeit für Erleichterung und Sicherheit sorgen und wie Du diese praxisorientiert einsetzen kannst.
Im Theorieteil erfährst Du, was die Aromapflege ist und wie sie wirkt. Im Praxisteil geben wir Dir konkrete Tipps & Tricks, wie Du im Alltag besser mit verschiedenen Situationen umgehen und Patient:innen individuelle Empfehlungen im Sinne der Gesundheitsberatung mit auf den Heimweg geben kannst.
Du erhältst wertvolles Arbeitsmaterial, damit eine Umsetzung im Berufsalltag nachhaltig und gut gelingen kann.
Theoretischer Teil
• Einführung in die Aromapflege
• Vorstellung Anwendungsformen
Praktischer Teil
• Wie wirkt Raumbeduftung im Wartezimmer?
• Schnelle Hilfe und Unterstützung in schwierigen Situationen
• Was kann man für die Selbstfürsorge tun?

Carmen Riegler ist Diplomierte Psychiatrische Gesundheits- und Krankenpflegerin und Absolventin der Weiterbildung Komplementäre Pflege - Aromapflege laut § 64 GuKG mit 17 Jahren Berufserfahrung. Sie hat die Aromapflege im Therapiezentrum Ybbs aufgebaut und implementiert und ist seit 2021 als Fachreferentin zum Thema Aromapflege bzw. Assistenz der Schulleitung bei uns tätig.
G u KGFortbildungsstund e n 16
Unsere faszinierende Schutzhülle Haut –ein lebenswichtiger Mikrokosmos
→ Fortbildung laut § 63, § 104c GuKG
Biologische Hautpflege mit pflanzlichen Ölen, Fetten und ätherischen Ölen ist einzigartig. Sie pflegt und schützt die Haut nicht nur, sondern geht buchstäblich „unter“ die Haut! Die Hautgesundheit ist für die Gesundheit des ganzen Menschen mitverantwortlich. Hierbei spielt das Hautimmunsystem eine besonders wichtige Rolle. Es entscheidet mit, ob ich mich in meiner Schutzhülle Haut wohl fühle oder nicht. Doch gerade diese Faktoren werden bei konventionellen Chemie-Kosmetikprodukten kaum beachtet. Und liest man deren INCI-Liste, kommt man aus dem Staunen nicht mehr heraus.
Inhalte
• Ein Einblick in den Mikrokosmos Haut
• Unsere Haut - ein lebenswichtiges Immunorgan
• Was versteht man unter biologischer Hautpflege?
• Wir lernen die Zusammenhänge zwischen Haut, Psyche und Immunsystem kennen
• Was sind die Hintergründe von Hautproblemen und Allergien?
• Wir lernen Pflanzenöle und Fette kennen und blicken auf neue Erkenntnisse aus der Forschung
• Native Pflanzenöle/-fette versus mineralische Öle/Fette (Mineralöle, Paraffine)
• Pflanzliche Wirkstoffe wie z.B. ätherische Öle versus erdölbasierte und synthetische Wirkstoffe wie z.B. Duftstoffe
WIEN
07. + 08.04.2025
Kurs-Nr. BH25-04-07
WEB-SEMINAR
25. + 26.11.2025
Kurs-Nr. BH25-11-25
INFOS
Referentin
Ruth von Braunschweig
Dauer, Zeit
2 Tage, jew. 9.00 – 17.00 Uhr 16 Maßnahmenstunden
Teilnehmer
max 20 Personen
Zielgruppe
Pflegepersonen, medizinisches Fachpersonal und alle Interessierte
Gebühr
279,00 € inkl. Seminarunterlagen, Arbeitsmaterial, Pausengetränke, Obst und Kekse. Bei Buchung WebSeminar inkl. Seminarpaket mit Seminarunterlagen und Arbeitsmaterial (per Post)
Ruth von Braunschweig studierte Biologie und Chemie in Göttingen. Sie ist Dipl.- Biologin und Heilpraktikerin mit den Schwerpunkten Aromatherapie, Aromapflege, Biologische Medizin, Biologische Hautpflege und Stressbewältigung. Sie hat eine Kosmetikfachschule für „Ganzheitliche Biologische Hautpflege“ aufgebaut und geleitet. Seit vielen Jahren ist sie Referentin für Aromapflege und Aromatherapie im In- und Ausland, sowie Autorin einiger maßgeblicher Fachbücher.





Ganzheitliche, bedürfnisorientierte
Gesundheitspflege beim Älterwerden
→ Fortbildung laut § 63, § 104c GuKG NEU G r undwissen erforderl i
Aromapflegeanwendungen sind in der geriatrischen Pflege vielseitig einsetzbar. Sie wirken sanft, bringen Linderung und unterstützen die Wirkung einzelner Pflegemaßnahmen. Aromapflege ist gerade für ältere Menschen mit besonderen Bedürfnissen das Mittel der Wahl, um Vertrauen, eine angenehme Atmosphäre oder Wohlbefinden zu schaffen. Sie erreicht jede Person dort, wo sie sich gerade befindet. Der individuelle Einsatz von Aromapflegeanwendungen im geriatrischen Umfeld ist somit nicht nur mit besonderen Momenten, sondern auch mit Würde, Respekt und einem Gefühl von Geborgenheit verbunden.
In diesem Seminar lernst Du die vielfältigen Einsatzmöglichkeiten von ätherischen Ölen, Hydrolaten und fetten Pflanzenölen in der Geriatrie (bei Multimorbidität) kennen. Du erfährst außerdem, wie die Aromapflege im Rahmen der Prophylaxen und bei speziellen sowie konkreten Pflegephänomenen wie z.B. Angst, Unruhe oder Schmerz unterstützend eingesetzt werden kann.
• Wohlbefinden, Ruhe und Sicherheit durch Aromapflege in der Geriatrie fördern
• Hautpflege: Bewährte, reichhaltige Pflanzenöle und darauf basierende Pflegeprodukte für die tägliche Hautpflege und zur Prophylaxe
• Anwendungsformen und die richtige Dosierung
• Förderung spezieller Kompetenzen durch Beschäftigungsangebote wie Duftreisen, Gedächtnis- und Riechtraining
• Best Practice: Fallbeispiele, nützliche Praxistipps, bewährte Produkte und deren Anwendungsmöglichkeiten
WIEN
31.03.2025
Fortbildungsstund e n 8
Kurs-Nr. AG25-03-31
23.09.2025
Kurs-Nr. AG25-09-23
INFOS
Referentin
Eva-Maria Rudorfer, BScN
Dauer, Zeit
1 Tag, jew. 9.00 – 17.00 Uhr 8 Maßnahmenstunden
Teilnehmer max 22 Personen
Zielgruppe
Pflegepersonen, medizinisches Fachpersonal und alle Interessierte mit Aromapflege-Grundwissen
Gebühr
179,00 € inkl. Seminarunterlagen, Arbeitsmaterial, Pausengetränke, Obst und Kekse
Eva-Maria Rudorfer, BScN ist Diplomierte Gesundheits- und Krankenpflegeperson mit 16 Jahren Berufserfahrung. Absolventin der Weiterbildung Komplementäre Pflege-Aromapflege und Wundmanagement (nach § 64 GuKG); hat einen universitären Abschluss in Pflegewissenschaft und langjährige Erfahrung als Fachreferentin zum Thema Aromapflege. Ist als Pflegeberaterin tätig und absolviert derzeit den Masterstudiengang ANP an der PMU Salzburg.

Fachseminar für Ihr Team in Ihrem
Dann sind wir genau der richtige Partner für Sie. Wir durften schon über 500 verschiedene Pflegeeinrichtungen in Österreich, Deutschland und Südtirol bei der Implementierung der Aromapflege begleiten. Alle unsere Fachreferent:innen sind Angehörige des gehobenen Dienstes für GuKG, die über eine mehrjährige Berufserfahrung im Bereich der Aromapflege verfügen. Also Wissenstransfer getreu unserem Motto: Von der Pflege - für die Pflege.
Alle unsere Fachseminare sind Fortbildungen laut § 63 bzw. § 104c GuKG, beinhalten umfassende Seminarunterlagen und schließen mit einer Teilnahmebestätigung ab. Die maximale Teilnehmerzahl pro Seminar ist auf 20 Personen begrenzt.
Folgende Aromapflege Fachseminare bieten wir Ihnen aktuell als Inhouse-Seminar an:
• Aromapflege Einführung, 2 Tage, 16 UE
• Aromapflege Fortsetzung, 2 Tage, 16 UE
• Aromapflege Praxistage, 2 Tage, 16 UE
• Schmerz lass nach, 1 Tag, 8 UE
• Aromapflege bei Demenz, 1 Tag, 8 UE
• Aromapflege in der Palliative Care, 1 Tag, 8 UE
• Aromapflege in der Geriatrie, 1 Tag, 8 UE
• Aromapflege im Wundmanagement. 1 Tag. 8 UE
• Aromapflege in Ordination und Ambulanz, 1 Tag, 8 UE
• Psychische Gesundheit fördern mit Aromapflege, 2 Tage, 16 UE
• Riechtraining fürs Gehirn, 1 Tag, 8 UE
• Vital und gesund durch Alltag & Beruf, 1 Tag, 8 UE (im Rahmen der betrieblichen Gesundheitsförderung)
• Maßgeschneidertes Aromapflege Inhouse-Seminar
houseSeminarmögl
Wir freuen uns über Ihre Anfrage, beraten Sie gerne und erstellen Ihnen ein maßgeschneidertes Angebot für ein Aromapflege Fachseminar in Ihrem Haus.

Simone Stoschek-Broll ist für das Seminarmanagement und die Koordination der Gesundheitsschule Evelyn Deutsch zuständig. Sie berät Sie gerne bei Fragen rund um die individuelle Fortbildung und zu innerbetrieblichen Schulungen. Auf Wunsch erstellt Sie auch ein E-Learning-Konzept für Ihr Team. seminare@aromapflege.com, +43 5672 64942-22
Individuell an die spezifische Anforderung der Pflegeeinrichtung angepasste Fortbildung
→ Fortbildung laut § 63, § 104c GuKG
Nach dem Besuch von Aromapflege-Fortbildungen ist die Motivation sehr hoch, das neuerworbene Fachwissen gleich im Pflegealltag einzubringen und umzusetzen. Jedoch tauchen in der Umsetzungsphase oder direkt bei der Anwendung im Berufsalltag immer wieder Fragen und Unsicherheiten auf, die während des Seminars nicht vorhersehbar waren. Oder Ihnen ist die Implementierung der Aromapflege bereits erfolgreich gelungen und Sie möchten diese nun optimieren, festigen und sogar erweitern?
Hier haben wir die passende Lösung: Sie legen die Themen-Schwerpunkte fest und unsere Expert:innen sorgen dafür, dass die Fortbildung präzise auf die Bedürfnisse, Herausforderungen und Interessen Ihrer Mitarbeiter:innen bzw. Pflegeeinrichtung zugeschnitten ist. Zusammenarbeit und Fokus sind die Schlüssel und wir stehen bereit, Sie auf diesem Weg zu begleiten.
Inhalte
• Individuelle Themenschwerpunkte und Zielsetzung nach Vorgabe (z.B. „Hautpflege“, „Wickel & Kompressen“, usw.)
• Fragenkatalog: Wir beantworten Fragen, die sich in der Umsetzungsphase oder bei der Anwendung im Pflegealltag ergeben
• Nachhaltigkeit: Vertiefung der aromapflegerelevanten Kernthemen
• Auffrischung/Optimierung: Für die kompetente, wirtschaftliche und nachhaltige Anwendung der Aromapflege
Carmen Riegler ist Diplomierte Psychiatrische Gesundheits- und Krankenpflegerin und Absolventin der Weiterbildung Komplementäre Pflege - Aromapflege laut § 64 GuKG mit 17 Jahren Berufserfahrung. Sie hat die Aromapflege im Therapiezentrum Ybbs aufgebaut und implementiert und ist seit 2021 als Fachreferentin zum Thema Aromapflege bzw. Assistenz der Schulleitung bei uns tätig. I n
TERMIN individuell vereinbar
INFOS
Referentin
Carmen Riegler
Dauer, Zeit
½ Tag, 1 Tag oder 2 Tage ab 4 – 16 Maßnahmenstunden
Teilnehmer
max 20 Personen
Zielgruppe
Pflegepersonen, medizinisches Fachpersonal und alle Interessierte
Gebühr auf Anfrage
Kontakt
Simone Stoschek-Broll
Seminarmanagement seminare@aromapflege.com +43 5672 64942-22
Nur innerbetrieblich auf Anfrage buchbar.


Leseecke im Flagship-Store Wien
Seminarraum im Aromapflegezentrum Wien


Natürlich für die Gesundheit
„Gegen jede Krankheit ist ein Kraut gewachsen“ heißt es nicht ohne Grund im Volksmund. Doch in den vergangenen Jahrzehnten ist viel altes Wissen in Vergessenheit geraten. Das Marketinggebrüll großer Pharmakonzerne, der oft trügerische Fortschritt der Schulmedizin und nicht zuletzt unsere Bequemlichkeit haben dazu beigetragen, dass wir unser wichtigstes Gut - unsere Gesundheit - oft stiefmütterlich behandeln und meist sorglos anderen überantworten.
Das möchten wir ändern! Wir wollen Dich für die Natur begeistern, Dein Gesundheitsbewusstsein wecken, Dich zum Nachdenken anregen und Türen aufstoßen.
I n houseSeminarmögl i c h G u KGFortbildungsstund e n 8
Pflegepersonen* erhalten Fortbildungsstunden (= Maßnahmenstunden).
1 Fortbildungsstunde (FBS) = 1 Unterrichtseinheit (UE) à 45 Minuten. Die Anzahl der absolvierten Maßnahmenstunden wird im Symbol angezeigt.
Seminar kann auch als innerbetriebliche Fortbildung für Teams bis maximal 20 Personen gebucht werden. Referent:in kommt persönlich ins Haus.
G r undwissen erforderl i
Teilnahme am Seminar setzt Aromapflege-Grundwissen über ätherische Öle, fette Pflanzenöle sowie deren Dosierung und Anwendung voraus.
Seminar ist neu und wird von uns zum ersten Mal angeboten.
Web-Seminar
Seminar ist live & interaktiv und findet zu einem festen Termin im Internet statt.
* Pflegepersonen sind gemäß § 63 bzw. § 104c GuKG verpflichtet, innerhalb von fünf Jahren 40 Fortbildungsstunden für Assistenzberufe bzw. 60 Fortbildungsstunden für den gehobenen Dienst zu absolvieren.



Ein faszinierender Einblick in die Welt der Forschung über ätherische Öle
→ Fortbildung laut § 63, § 104c GuKG
Ätherische Öle sind ideale Naturstoffe für eine Vielzahl von Duftwirkungen. Die Riechzellen der Nase sind eng mit dem Emotions- und Gedächtniszentrum im Gehirn verbunden. Duftstoffe können auch direkt über Haut, Atmung oder Magen-Darm unser Blut erreichen.
Ihre Wirkungen auf Gehirnzellen (stimulierend oder beruhigend) und die Bedeutung von Riechrezeptoren in verschiedenen Körperzellen, wo sie Heilungsprozesse beschleunigen, die Verdauung fördern, den Herzschlag beeinflussen, Lungenerkrankungen lindern und Tumorwachstum hemmen können, werden diskutiert. Im Seminar erfährst Du, wie Pheromone die zwischenmenschliche Kommunikation beeinflussen können, einschließlich Partnerwahl, Vertrauen und Kommunikation. Dies alles zeigt, warum es heute wichtig ist, sich mit Düften und ihrer Bedeutung für unser Leben zu beschäftigen.
Inhalte
• Allg. Überblick Zelluläre Prozesse zur Duftwirkung
• Aufbau und Funktion der Riechschleimhaut und nachgeschalteter Gehirnareale
• Wirkungen von Duftstoffen auf Emotionen, Triebe und Erinnerungen
• Duftwirkungen über Haut, Atmung und Magen-Darm auf Konzentration, Aufmerksamkeit sowie Stress- und Angstbewältigung
• Riechrezeptoren außerhalb der Nase als neue Ziele für Therapie und Diagnose
• Duftstoffe und Krebstherapie
WIEN
05.07.2025
Kurs-Nr. HH25-07-05
INFOS
Referent
Prof. DDDr. Hans Hatt
Dauer, Zeit
1 Tag, 9.00 – 16.00 Uhr
7 Maßnahmenstunden
Teilnehmer
max 40 Personen
Zielgruppe
Pflegepersonen, medizinisches Fachpersonal und alle Interessierte
Gebühr
179,00 € inkl. Seminarunterlagen, Arbeitsmaterial, Pausengetränke, Obst und Kekse
Prof. DDDr. Hans Hatt ist seit Jahrzehnten einer der weltweit führenden Geruchsforscher. Er hat in den Bereichen Zoologie, Humanphysiologie und Medizin promoviert und ist Professor für Zellphysiologie an der Ruhr-Universität in Bochum. Er ist bekannt dafür, sein hochwissenschaftliches Fachwissen in seinen Vorträgen auf eine unnachahmliche Weise verständlich zu vermitteln. Dabei setzt er viel Witz und Charme ein, um die Bedeutung des Geruchssinns zu betonen.

TIROL
16.05.2025
Kurs-Nr. FG25-05-16
WIEN
30.04.2025
Kurs-Nr. FG25-04-30
19.09.2025
Kurs-Nr. FG25-09-19
INFOS
Referentin
Evelyn Deutsch-Grasl, AE + Carmen Riegler
Dauer, Zeit
1 Tag, 9.00 – 17.00 Uhr 8 Maßnahmenstunden
Teilnehmer
max 20 Personen
Zielgruppe
Pflegepersonen, medizinisches Fachpersonal, Berufstätige und alle Interessierte
Gebühr
179,00 € inkl. Seminarunterlagen, Arbeitsmaterial, Pausengetränke, Obst und Kekse
Feel good Seminar mit der Wirkkraft der Aromapflege
→ Fortbildung laut § 63, § 104c GuKG


Bist Du im Alltag und Beruf stark gefordert? Suchst Du nach einfachen und wirksamen Methoden, um Herausforderungen besser zu meistern? Bist Du offen für Heilpflanzenkunde & ätherische Öle und willst deren Kraft für Dich nutzen?
Dann bist Du bei diesem Seminar richtig! Du lernst, auf natürliche Weise Dein Wohlbefinden zu fördern, Stress hinter Dir zu lassen, Konflikte gelassener zu nehmen und Deine Widerstandskraft zu stärken. Besonders in Zeiten erhöhter Belastung oder in Krisensituationen kannst Du mit einfachen und natürlichen Mitteln Deine Gesundheit unterstützen und fördern. Im Theorieteil erfährst Du was die Aromapflege ist und wie sie wirkt. Im Praxisteil probierst Du viele konkrete Tipps & Tricks aus, wie Du im Alltag besser mit belastenden Situationen umgehen kannst. Du lernst praxisnah, welche ätherischen Öle und andere Naturprodukte Dich dabei unterstützen.
Theoretischer Teil
• Eine kurze Einführung in die Aromapflege
• Wirkungsbereich der Aromapflege
Praktischer Teil
• Methoden für die Arbeit: bei Müdigkeit und Erschöpfung, bei nachlassender Konzentration, in akuten Stresssituationen, in Erkältungszeiten, bei körperlichen Belastungen, Nachmittagstief/“Suppenkoma“
• Methoden für zuhause: Bei nervösen Magenbeschwerden, bei Schlaflosigkeit, bei ständigem Gedankenkarussell, bei Erschöpfungssymptomen, bei Antriebslosigkeit, bei einem geschwächtem Immunsystem
Evelyn Deutsch-Grasl, AE + Carmen Riegler
Symptome wahrnehmen und mit ätherischen Ölen & Heilpflanzen vorbeugen
→ Fortbildung laut § 63, § 104c GuKG
Du bist häufig gestresst und es fällt Dir zunehmend schwer, den Anforderungen Deines Alltags gerecht zu werden? In der Familie, im Freundeskreis oder unter Kollegen sind Menschen, deren Verhalten Dir Sorge macht? Die Zahl der an depressiven Episoden, Burnout und chronischen Depressionen Erkrankten steigt zunehmend an.
Dieses Seminar verschafft Dir einen Überblick zu den Themen Stress, Stresstypen, Burnout und Depression. Aromapflege ersetzt selbstverständlich keine Therapie, doch gerade vorbeugend und begleitend können mit hoch wirksamen, naturreinen Pflanzenölen oder auch Heilpflanzenpräparaten Befindlichkeitsstörungen und Krankheiten gelindert werden.
Inhalte
• Reaktion des Körpers auf Stress - unterschiedliche Stresstypen
• Unterschied zwischen Burnout und Depression
• Ätherische Öle und Heilpflanzen vorbeugend und begleitend anwenden
• Resilienz - das Immunsystem der Seele
• Best Practice: Entspannungsübungen, Duftreise, Mischen eines Anti-Stress-Duftes
WIEN
07.05.2025
Kurs-Nr. WS25-05-07
17.10.2025
Kurs-Nr. WS25-10-17
INFOS
Referentin
Cornelia Mögel
Dauer, Zeit
1 Tag, 9.00 – 17.00 Uhr 8 Maßnahmenstunden
Teilnehmer max 20 Personen
Zielgruppe Pflegepersonen, medizinisches Fachpersonal und alle Interessierte
Gebühr
179,00 € inkl. Seminarunterlagen, Arbeitsmaterial, Pausengetränke, Obst und Kekse
Cornelia Mögel ist seit vielen Jahren als freie Dozentin für Aromapflege tätig. Die examinierte Krankenschwester, Heilpraktikerin, Aroma- und Wundmanagementbeauftragte arbeitet in Teilzeit seit mehr als 30 Jahren im Notfallzentrum des Münchner Klinikums Neuperlach. Sie leitet dort den Aroma-Arbeitskreis mit 80 Teilnehmer:innen und wendet seit vielen Jahren Aromapflege als komplementäre Pflegemethode an.

TIROL
26.09.2025
Kurs-Nr. WJ25-09-26
WIEN
28.02.2025
Kurs-Nr. WJ25-02-28
03.10.2025
Kurs-Nr. WJ25-10-03
INFOS
Referentin
Carmen Riegler
Dauer, Zeit
1 Tag, 13.00 – 19.00 Uhr 6 Maßnahmenstunden
Teilnehmer
max 22 Personen
Zielgruppe
Alle Interessierte und Pflegepersonen, medizinisches Fachpersonal
Gebühr
179,00 € inkl. Handout, Arbeitsmaterial, Pausengetränke, Obst und Kekse

Praktische Tipps wie pflanzliche Mittel unterstützen können
→ Fortbildung laut § 63, § 104c GuKG
Du leidest unter Hitzewallungen, Schlafstörungen, Scheidentrockenheit, trockene Haut, Stimmungsschwankungen, Reizbarkeit – also all die typischen Wechseljahresbeschwerden? Ausgeglichen und entspannt das Frau sein in den Wechseljahren, trotz Beschwerden, zu genießen, hängt von etlichen Faktoren ab. Ein universelles Rezept gibt es nicht. Denn so einzigartig wie jede Frau ist, so unterschiedlich können die Ausprägung und Intensität der Beschwerden variieren. Die gute Nachricht: In diesem Seminar erfährst Du allgemeine und konkrete Tipps, wie Du Wechseljahrbeschwerden mit pflanzlichen Mittel nützen kannst, um natürlich vorzubeugen und die Symptome in den Wechseljahren zu lindern.
Theoretischer Teil
• Was sind die Wechseljahre - was passiert in dieser Zeit?
• Typische Beschwerden und wie pflanzliche Mittel helfen können
• Tipps, wie Du zusätzlich Beschwerden vorbeugen und reduzieren kannst
• Balance und Wohlbefinden im Alltag in den Wechseljahren
Praktischer Teil
• Praktische Begleiter zur Stimmungsaufhellung und für die gute Laune
• Entspannende Atemübungen für mehr innere Ruhe
• Schritt-für-Schritt-Anleitung für eine innere Kur
• DIY Intim-Pflegeöl zur Pflege der Vaginalschleimhaut
• Anleitung für selbstgemachte, pflegende Feuchttücher
Carmen Riegler ist Diplomierte Psychiatrische Gesundheits- und Krankenpflegerin und Absolventin der Weiterbildung Komplementäre Pflege - Aromapflege laut § 64 GuKG mit 17 Jahren Berufserfahrung. Sie hat die Aromapflege im Therapiezentrum Ybbs aufgebaut und implementiert und ist seit 2021 als Fachreferentin zum Thema Aromapflege bzw. Assistenz der Schulleitung bei uns tätig.
Mit Heilpflanzen unsere Haustiere gesund halten und gesund pflegen
Tiere reagieren hervorragend auf die Behandlung mit Heilpflanzen. In diesem Seminar lernst Du, wie Du Deine Lieblinge mit Pflanzen pflegen und behandeln kannst. Viele Befindlichkeitsstörungen lassen sich wunderbar pflanzlich therapieren und manch eine Krankheit kann begleitend zur synthetischen Medizin des Tierarztes mit pflanzlichen Wirkstoffen unterstützt werden. Ziel ist, die Selbstheilungskräfte unserer Haustiere bestmöglich anzuregen und so wenig wie möglich in die naturgemäße Funktion des Körpers einzugreifen. Allerdings lassen sich die Wirkungen der Pflanzen nicht eins zu eins vom Menschen auf das Tier übertragen. Die unterschiedlichen Wirkungen auf die Tierarten und welche Möglichkeiten Du zuhause hast, um Deinem Schützling zu helfen, lernst Du an diesem Tag.
Inhalte
• Veterinärphytotherapie - was ist das?
• Geschichte der Veterinärphytotherapie
• Kleine pflanzliche Hausapotheke für Haustiere
• Pflanzliche Behandlung bei Magen- und Darmbeschwerden
• Pflanzliche Behandlung bei Wunden
• Pflanzliche Parasitenprophylaxe
• Praxisteil: Tinkturen und Salben für Tiere selber herstellen
WEB-SEMINAR
28.11.2025
Kurs-Nr. TE25-11-28
INFOS
Referentin
Dr. in med. vet. Alexandra Nadig
Dauer, Zeit
1 Tag, 9.00 – 17.00 Uhr
Teilnehmer max 40 Personen
Zielgruppe Alle Interessierte
Gebühr
179,00 € inkl. Seminarpaket mit Seminarunterlagen (per Post)
Dr.in med. vet. Alexandra Nadig ist Tierärztin mit Schwerpunkt Phytotherapie, Referentin und Buchautorin. Nach ihrer Doktorarbeit folgten 2 Jahre als Assistenztierärztin in einer großen Tierklinik. Von 2010 bis Ende 2013 leitete sie eine eigene kleine Praxis in einem Tierheim. Bis 2020 führte sie in Lorch ihre Kleintierpraxis mit dem Schwerpunkt Phytotherapie. Sie engagiert sich als Referentin und Autorin (z.B. „Heilpflanzen für Hunde: Wirkungsweise, Rezepturen und Anwendung“, KOSMOS Verlag 2018).




Krankheitserreger bei Katze, Hund & Co mit Heilpflanzen und Kräutern behandeln
Web-Seminar
In diesem Seminar gehen wir auf die spezifischen Krankheitserreger, wie Bakterien, Viren, Pilze und Parasiten ein. Die Erreger werden erklärt und ihre schulmedizinische Behandlung aufgezeigt. Antibiotika, Antiparasitika & Co wirken heute immer schlechter. Immer mehr Resistenzen entstehen und die Pharmakologie versucht mit immer stärkeren Mitteln dagegen anzukämpfen. Kann das die Lösung sein?
Die Lösung liegt in den Naturstoffen, die auch nach Jahrmillionen keine Resistenzen hervorgebracht haben. Wir sehen uns das Potential dieser Wirkstoffe an und ihre praktische Anwendung beim Haustier.
Inhalte
• Infektionskrankheiten beim Haustier, was ist das?
• Bakterien - die Gefahr der Resistenzen und ihre Vermeidung durch pflanzliche Antibiotika
• Phytobiotika - pflanzliche Antibiotika
• Viren - hochkomplizierte Erreger, die sich durch pflanzliche Immunmodulation bekämpfen lassen
• Pilze - Gefahren und Auftreten von Pilzen und deren pflanzliche Behandlung
• Parasiten - Endo- und Ektoparasiten
• Was kann man pflanzlich vorbeugend tun?
• Wie behandelt man pflanzlich eine Infektion?
WEB-SEMINAR
29.11.2025
Kurs-Nr. TF25-11-29
INFOS
Referentin
Dr. in med. vet. Alexandra Nadig
Dauer, Zeit 1 Tag, 9.00 – 17.00 Uhr
Teilnehmer max 40 Personen
Zielgruppe Alle Interessierte
Gebühr
179,00 € inkl. Seminarpaket mit Seminarunterlagen (per Post)
Dr.in med. vet. Alexandra Nadig ist Tierärztin mit Schwerpunkt Phytotherapie, Referentin und Buchautorin. Nach ihrer Doktorarbeit folgten 2 Jahre als Assistenztierärztin in einer großen Tierklinik. Von 2010 bis Ende 2013 leitete sie eine eigene kleine Praxis in einem Tierheim. Bis 2020 führte sie in Lorch ihre Kleintierpraxis mit dem Schwerpunkt Phytotherapie. Sie engagiert sich als Referentin und Autorin (z.B. „Heilpflanzen für Hunde: Wirkungsweise, Rezepturen und Anwendung“, KOSMOS Verlag 2018).

Auf unserer Webseite findest Du alle aktuellen Termine und weitere spannende Kurzvorträge: aromapflege.com/ kurzvortraege
Kurzvortrag
Referentin
Mag. a Kathrin Sperker, MPH Kosten
15,00 € inkl. Getränke
Referentin
Evelyn Deutsch-Grasl, AE Kosten
15,00 € inkl. Getränke
Referentin
Mag. a Kathrin Sperker, MPH Kosten
15,00 € inkl. Getränke
Referentin
Marina Prskalo, BScN Kosten
15,00 € inkl. Getränke
Referentin
Maria Christina Margreiter, BScN Kosten
Eintritt frei
In unseren Gesundheitsschulen in Wien und Tirol bieten wir regelmäßig 90-minütige Kurzvorträge an. Diese eignen sich ideal für alle, die sich schnell und fundiert über spezielle oder aktuelle Themen informieren möchten. Sie sind eine hervorragende Einführung in unsere umfangreicheren Seminare. Hier findest Du nun eine Auswahl an Kurzvorträgen:
Präsenzveranstaltungen für alle Interessierten und Fachpersonal
Gut durch die Säuglingszeit
Natürliche Hautpflege von Anbeginn Du hast keinen Babysitter? Gerne kannst Du Dein Kind mitbringen!
Urlaub, Sommer, Sonne
Praktische Hautpflegetipps, um das Sommerfeeling in voller Gänze zu genießen
Natürliche Begleiter in der Schwangerschaft
Was tun bei Übelkeit, Hautpflege, Vorbereitung auf die Geburt
SKINFOOD
Tauche ein in die Welt der gesunden, natürlichen Hautpflege und profitiere von diesem Wissen. Lass Dich von den praktischen Beispielen und Anwendungen überzeugen!
Lesung mit Maria Christina MargreiterWunderwerk Nase

Kurzvorträge in Präsenz und online für Pflegepersonen, medizinisches Fachpersonal, pflegende Angehörige und Interessierte mit Aromapflege-Grundwissen
Referentin: Eva-Maria Rudorfer
Aromapflege bei Demenz
Düfte als Schlüsselreize in der Pflege von demenziell erkrankten Menschen
Schmerz lass nach
Aromapflege als wertvolle Ergänzung bei der pflegerischen Betreuung von Schmerzpatient:innen
Aromapflege in der Palliative Care
Wertvolle Unterstützung bei der Begleitung von Menschen im letzten Lebensabschnitt
Aromapflege im Wundmanagement
Gesundheitspflege zur Bewahrung der intakten Haut
Aromapflege in der Geriatrie
Ganzheitliche, bedürfnisorientierte Gesundheitspflege beim Älterwerden
Für die Fach-Kurzvorträge erhältst Du eine Teilnahmebestätigung und Fortbildungsstunden lt. § 63, § 104c GuKG. Alle Informationen findest Du unter aromapflege.com/ kurzvortraege
Hier geht‘s zum Produktkatalog
Als Seminarteilnehmer:in der Aromapflege Gesundheitsschule Evelyn Deutsch wirst Du nach Abschluss Deines ersten Seminares (Präsenz-, Online- oder E-Learning-Seminar) bei uns als VIP-Kund:in aufgenommen.
Dadurch erhältst Du exklusive Vorteile und kaufst zu günstigeren Konditionen ein.
Deine Vorteile als VIP-Kund:in
• 10% VIP-Rabatt auf alle Einkäufe
Der Rabatt gilt für alle unsere Produkte. Ausgenommen sind jedoch Bücher, Seminare, Themenabende und Behandlungen in unserem Naturkosmetikstudio in Lechaschau.
• Gratis Aromakoffer SMALL bei Erstbestellung über 100,00 €: Ab einem Mindestbestellwert von 100,00 € gibt es den Aromakoffer SMALL gratis zu Deinem Einkauf. Unsere bestehenden Kund:innen können den Aromakoffer SMALL zu einem attraktiven Sonderpreis in unserem OnlineShop erwerben. Bitte beachte: Der Koffer wird ohne Inhalt geliefert.
• Exklusive Infos über Produkte, Seminare und Verkaufsaktionen.



Impressum
Bitte melde Dich unter Angabe Deines Namens, Deiner Adresse, einer Telefonnummer, wenn möglich einer E-Mail-Adresse und der Kursnummer bzw. dem Kursnamen plus Kurstermin an. Möglich ist dies bevorzugt auf unserer Webseite www.aromapflege.com oder per Fax, Post und E-Mail.
Die Seminarplätze werden in der Reihenfolge der eingehenden Anmeldungen vergeben. Nach erfolgter Anmeldung erhältst Du von uns per E-Mail, eine Buchungsbestätigung. Damit ist Dein Seminarplatz bindend reserviert. Bei Seminarbuchung ist keine Anzahlung nötig. Wir senden Dir ca. 6 Wochen vor dem Seminartermin eine Rechnung zur Überweisung. Die angegebenen Gebühren verstehen sich inklusive der gesetzlichen Mehrwertsteuer.
Eine Stornierung ist bis zu 8 Wochen vor dem Seminartermin kostenlos möglich. Bei späterem Rücktritt – egal aus welchen Gründen - müssen wir Dir die Seminargebühr in Rechnung stellen. Es sei denn, es springt jemand von der Warteliste ein oder Du nominierst selbst eine Ersatzteilnehmer:in. Wir bieten für jedes Seminar eine Stornoversicherung in Höhe von 15,00 € an.
Genaue Infos dazu findest Du in den AGB auf unserer Webseite www.aromapflege.com.
Muss von uns ein Seminar abgesagt oder verschoben werden, wirst Du davon rechtzeitig per E-Mail verständigt. Ansprüche gegenüber der Aromapflege GmbH sind daraus nicht abzuleiten.
Aromapflege GmbH, Sepp-Haggenmüller-Straße 6, 6600 Lechaschau, Österreich Änderungen, Irrtümer, Satz-, Tipp- und Druckfehler vorbehalten.
Copyright © 2024 Aromapflege GmbH
Bildindex: Bildindex: Dieter Kühl (www.dk-foto.at): Cover, 2, 6, 7, 12, 26 (o), 34, 38 (o), 54; Aromapflege GmbH/Holly Kellner: 5, 42, 53, 56; stock.adobe.com/Olivier Le Moal: 10; stock.adobe.com/LIGHTFIELD STUDIOS: 26 (u.); Dr. Gerda Dorfinger 30 (o., m.); stock.adobe.com/ARTFULLY-79: 30 (u.); Shutterstock.com/Monkey Business Images (38 m.l.); shutterstock.com/Photographee.eu (38 m.r., u.); Aromapflege GmbH/Alexander Wagner: 44; stock.adobe.com/Rugercm: 50 (o.)stock.adobe.com/KK-Fotografie: 50 (u.l.); Aromapflege GmbH: 50
Grafik: markushechenberger.net Werbeagentur
KONTAKT
Aromapflege GmbH
Schule Wien
Margaretenstraße 52, Eingang Kettenbrückengasse 2 (Seminarglocke) 1040 Wien
Schule Tirol
Sepp-Haggenmüller-Straße 6, 6600 Lechaschau
T Österreich: +43 5672 64942
T Deutschland: +49 8362 9390982
F +43 5672 64970
info @ aromapflege.com www.aromapflege.com
/aromapflege

